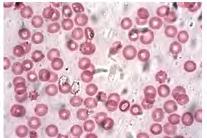

УДК 57*кл8(075.3)
Б65
Автори: Оксана Андерсон, Андрій Чернінський, Марина Вихренко, Арсеній Андерсон
Відповідає Модельній навчальній програмі «Біологія. 7–9 класи» для закладів загальної середньої освіти (авт. Балан П.Г., Кулініч О.М., Юрченко Л.П.), рекомендованій Міністерством освіти і науки України (наказ МОН від 06.09.2023 № 1090).
Андерсон О.А. та ін. Б65 Біологія: підруч. для 8 кл. закладів заг. середньої освіти/ О.А. Андерсон, А.О. Чернінський, М.А. Вихренко, А.О. Андерсон. Київ: Школяр, 2025. 256 с.: іл. ISBN 978-617-7735-02-0
УДК 57*кл8(075.3)
Рекомендовано Міністерством освіти і науки України (Наказ № 347 від 21.02.2025 р.) © Андерсон О.А., Чернінський А.О., Вихренко М.А., Андерсон А.О., 2025 © УВЦ «Школяр», 2025 ISBN 978-617-7735-02-0 © УВЦ «Школяр», художнє оформлення, 2025
знати, як побудовано саме цей підручник. Тож спочатку погортайте його сторінки й ознайомтеся зі структурою. Щоб підручником було зручно користуватися, кожен параграф
сприймати інформацію,
пошуку наукової інформації. Опрацювання
Кожен крок роботи зі
від того, який її вид пропонується виконати.
прочитайте
сформулюйте мету, доберіть об’єкти дослідження, складіть план лабораторного дослідження, зробіть висновки; виконайте дослідницький практикум
працюйте в команді: вчіться разом порівнювати, аналізувати, робити висновки, складати
ристанням набутих раніше знань. Завдання, що вимагають розгорнутої відповіді, спонукатимуть до роздумів
питаннями, пошуками відповідей за допомогою наукової літератури. Тестові завдання рубрики
власних навчальних досягнень, усвідомити прогалини в знаннях, сформувати навички роботи з тестовими завданнями
зовнішнього незалежного оцінювання.
Підручник містить електронний
краще розуміти та вивчати навчальний матеріал. Він представлений QR-кодами у різних розділах підручника, зокрема у параграфах
Виконавши завдання рубрики
нень», ви отримаєте оцінку за 12-бальною шкалою, яка
електронну пошту. Якщо у вас немає можливості сканувати QR-коди, на останній сторінці наявне посилання, яке веде до головної сторінки електронного додатка. Там ви зможете знайти всі інтерактивні матеріали, доступні в підручнику, та перейти до їх виконання. Водночас пам’ятайте, що сучасна
але дуже складна багатогранна наука. А шкільний

мистецтва, рукописи. Одним з унікальних видань, які дійшли до нашого часу, є Ізборники Святослава 1073 та 1076 року — найстаріші пам’ятки середньовічної книжності й мистецтва часів Київської Русі (іл. 1).
Науки, які вивчають організм людини. Особливості будови й функціонування організму людини є об’єктами вивчення біологічних наук. До них належать анатомія, морфологія, фізіологія, цитологія, гістологія, біохімія, імунологія, генетика, екологія тощо (див. форзац І). Відкриття в цих науках стали підґрунтям для розвитку взаємопов’язаних прикладних наук про організм людини. Наприклад, генетика людини це
хвороби, методи

Відповідно до цього
здоров’я.
здоров’я передбачає цілісність і нормальність будови тіла, нормальний перебіг життєвих процесів за різних (не екстремальних) умов. Психічне здоров’я це нормальний перебіг процесів мислення, пам’яті, уваги, емоцій, почуттів тощо. Соціальне здоров’я характеризує нормальність взаємодії конкретної людини з іншими членами суспільства, організації роботи, побуту, відпочинку тощо. Cкладники здоров’я є взаємопов’язаними (іл. 3).
На здоров’я можуть впливати різні чинники: спадковість, якість середовища існування, спосіб життя людини, рівень розвитку та доступність медичної допомоги, санітарно-гігієнічні умови життя та профілактичні заходи (іл. 4). Вивчення особливостей функціонування організму людини, впливу різноманітних чинників на нього допомагає сформувати принципи здорового способу життя, зокрема раціонального харчування, забезпечення певного рівня фізичної активності, уникнення шкідливих звичок. Хвороба істотне порушення здоров’я, яке супроводжується зниженням якості життя та порушенням будови й життєдіяльності організму.
Перелік відомих хвороб та їх класифікація затверджені в Міжнародному класифікаторі хвороб, розробленому ВООЗ.
Іл. 3. Складники здоров’я
Іл. 4.
гічної науки. Значення досягнень біології
молекулярна біологія дає інформацію стосовно зв’язків генів
організмів. Біотехнологічні методи дозволяють виробляти
медицини сполуки (антибіотики, вітаміни, антитіла).
Іл. 5. Давньогрецький лікар, реформатор античної медицини Гіппократ (460–370 рр. до н. е.)

Іл. 6. Збудник натуральної
(вірус)

цукрового
в будові тканин організму внаслідок уроджених
дити діагностування онкологічного захворювання (іл. 7). Цитологічні методи вивчення будови клітин уможливлюють виявлення спадкових захворювань, наприклад пов’язаних зі зміною кількості хромосом (як-от синдром Дауна). Мікробіологічні методи дозволяють виділити з організму й розпізнати збудників деяких інфекційних хвороб.
Розвиток молекулярної
методів. Так, полімеразна ланцюгова реакція (ПЛР) уможливлює виявлення збудників хвороб в організмі за їхнім генетичним матеріалом.
Зміни в будові внутрішніх
хірургічного втручання, застосувавши
випромінювання (іл. 8). Його використання є
(КТ), яка дозволяє отримувати тривимірні зображення органів. Ще більші можливості дає магнітно-резонансна томографія (МРТ). Низка методів скерована на вивчення функціонування внутрішніх органів: електрокардіографія реєструє електричну активність серця, електроенцефалографія головного мозку, спірометрія оцінює параметри дихання. Побачити внутрішні порожнини (шлунка, кишки) можна за допомогою тонких пристроїв з оптичними зондами ендоскопів.
Іл. 7. Гістологічне дослідження (вивчення будови тканини)

Іл. 8. Використання рентгенівського випромінювання в медицині

могли порахувати навіть кількість нервових клітин — тих, що в дорослому стані не діляться, а отже задачка, здавалося б, простіша. Вважалося, що їх 100 млрд, але сучасніші оцінки вказують
на 88 млрд. За певною класифікацією в організмі людини виділяють понад 400 головних типів клітин.
За особливостями будови виокремлюють чотири основні типи тканин:
епітеліальні, сполучні, м’язові, нервова.
Епітеліальні тканини. Епітеліальні тканини вкривають поверхню тіла та слизових оболонок, відмежовуючи організм від довкілля, а також формують залози. Екзокринні залози вивільняють утворювані речовини назовні або в порожнини тіла, а ендокринні у кров. Клітини епітеліїв розміщуються
пластинці, яка є продуктом життєдіяльності клітин епітеліїв і сполучної тканини, що розміщується під базальною пластинкою.
клітини разом, бере участь у регуляції їхнього розвитку й росту. Епітеліальні








тракту.
мають численні війки, які зумовлюють рух слизу в певному напрямку. Цей епітелій покриває слизові оболонки дихальних шляхів. Багатошарові епітелії поділяють на зроговілий та незроговілий. Верхній шар клітин зроговілого епітелію відмирає й формує лусочки, основною речовиною яких є білок кератин. Клітини незроговілого епітелію розташовані в кілька шарів, але верхні не відмирають. Цей різновид утворює, зокрема, слизові оболонки ока й ротової порожнини. Сполучні тканини. Особливістю цих тканин є велика кількість міжклітинної речовини, склад і властивості якої істотно визначають їхні функції. Сполучні тканини поділяють на власне сполучні тканини, сполучні тканини зі спеціальними властивостями (наприклад жирова, ретикулярна), скелетні тканини (кісткова, хрящова), кров і лімфу. Поміж власне сполучних тканин вирізняють пухку й щільну сполучну тканини (іл. 10). Міжклітинний простір цих тканин містить велику кількість волокон, утворених білками еластином і
геном. Міжклітинну речовину власне сполучних тканин утворюють основні клітини фібробласти. Надалі фібробласти перестають утворювати міжклітинну речовину й перетворюються на фіброцити.
Іл. 10. Сполучні тканини







містять велику кількість
підшкірну жирову клітковину тощо. Ретикулярна тканина утворює підтримуючий каркас для органів кровотворення та імунної системи. Скелетна сполучна тканина формує кістки та хрящі.
хрящової тканини здатні до поділу й утворення міжклітинної речовини. Надалі вони частково втрачають
тивість утворювати міжклітинну речовину. Такі клітини
вушну раковину тощо. Кісткова
складниками яких є
розглянемо
й забезпечують транспортну функцію, що буде розглянуто далі. М’язові тканини. Клітини м’язових тканин мають здатність до скорочення, що зумовлено функціонуванням у їхній цитоплазмі
лексів білків, зокрема актину й міозину. У м’язових тканинах порівняно невелика кількість міжклітинної речовини. Розрізняють посмуговану й гладеньку м’язові тканини.
скелетну й серцеву (іл. 11).
Іл. 11. Різновиди м’язової тканини




особливість зумовлює
язик
кими клітинами кардіоміоцитами, внутрішній уміст яких організовано подібно до скелетних м’язових волокон. Це обумовлює більшу силу скорочення серцевого м’язу порівняно з іншими внутрішніми органами. Вивчення будови тканин уможливлює застосування оптичного мікроскопа. Щоб впевнитися в цьому, проведімо лабораторне дослідження будови тканин, використавши мікропрепарати. Гладенька м’язова тканина складена з веретеноподібних клітин — міоцитів. Це одноядерні клітини, цитоплазма яких містить велику кількість скоротливих білків (іл. 12, а). Цією тканиною утворені м’язові шари стінок внутрішніх органів, наприклад, кровоносних судин, травної та видільної систем тощо. Нервова тканина. Основні клітини нервової тканини — нейрони — мають численні, часто дуже довгі відростки, якими ці клітини контактують з іншими нейронами, а також із м’язами й залозами. Допоміжні клітини нервової тканини — гліальні — виконують опорну, трофічну й захисну функції, що є необхідними для функціонування нейронів (іл. 12, б, в). Нервова тканина формує нервову систему. Іл. 12. Будова тканин:
тканина (мікрофотографія); б нервова тканина (мікрофотографія); в схематичне зображення нервової тканини




що клітина й організм є біологічними системами. Ці системи є відкритими, тобто отримують енергію з навколишнього середовища й обмінюються з ним речовиною та інформацією. Організм людини як біологічна система. Пригадайте, що світ живого організований у вигляді сходинок, які називають рівнями організації живої природи. Рівні організації





різною.
провести досить чітку межу (іл. 14). Однак жоден орган не може функціонувати абсолютно незалежно від інших частин
влює
спільної функції. Фізіологічна система органів сукупність органів, які часто анатомічно поєднані й функціонально взаємопов’язані.
організмі людини виокремлюють такі фізіологічні системи органів: опорно-рухова, яка забезпечує формування структури тіла, механічний захист органів, здатність
до різноманітних рухів; дихальна, яка постачає до організму кисень та
кровоносна, яка вможливлює транспортування різноманітних речовин по організму, а також бере участь


та формування програми
імунна, яка забезпечує підтримку генетичної сталості організму й захист від збудників захворювань; статева, яка відповідальна за процеси, пов’язані з розмноженням (іл. 15).
Анатомічно деякі системи утворені органами, які формують відносно відокремлені частини
Та є системи органів, складені з
нальні системи органів. Функціональна система
середовище організму сприймають спеціалізовані рецепторні клітини. Після оброблення ця інформація передається до органів, які забезпечують реакцію організму відповідно до умов існування. Гуморальна регуляція здійснюється за допомогою хімічних речовин, які виділяються у внутрішнє середовище організму. Основними регуляторними речовинами є гормони, які виділяються в кров ендокринними залозами. Вони досягають органів і впливають на їхні клітини. Згідно з уявленнями сучасної науки, імунна регуляція
запобігання інфекціям різної природи, знешкодження генетично змінених клітин власного організму,
нього середовища та підтримки сталості
середовища необхідна узгоджена робота нервової та ендокринної систем, яка обумовлюється їхнім взаємозв’язком. Взаємопов’язаний вплив нервової та гуморальної регуляції на організм називають
(іл. 16), з чим ви більш детально ознайомитеся
Іл. 16. Нейрогуморальна
Україною (усереднені дані)
Завдання 1. Найбільший
тя поміж населення
А травми
Б онкологічні хвороби
В серцево-судинні хвороби
Г інфекційні та паразитарні
Завдання 2. Правильну
Самоконтроль
1. Наука, яка вивчає
А екологія
Б анатомія
В генетика
Г фізіологія
2. Винайдення вакцинації
смертності від
А травм та опіків
Б інфекційних захворювань
В онкологічних захворювань
Г серцево-судинних захворювань
3. Унаслідок проведених досліджень
вищений рівень холестерину
було застосовано, —
А мікробіологічний
Б цитологічний
В гістологічний
Г біохімічний
4. Розпізнайте тканину, мікрофотографію якої
подано.
А нервова
Б м’язова
В хрящова
Г епітеліальна


5. Перелік органів організму людини наведено в рядку А нирки, миготливий епітелій
Б шлунок, кубічний епітелій
В серце, легені Г кров, печінка
6. Система органів, яка забезпечує транспортування речовин
нізму людини, — це
А травна
Б нервова
В кровоносна
Г опорно-рухова
7. Яке спадкове захворювання
А грип
Б малярію
В дизентерію
Г синдром Дауна
8. Здатністю до скорочення характеризуються клітини А одношарового плоского епітелію Б посмугованої м’язової тканини
В пухкої сполучної тканини Г кісткової тканини
9. Зображення


Тестові завдання з однією


11. На уроці біології учень й учениця
12. Доберіть правильне продовження кожного наведеного речення.

темі. Організм як відкрита система. Наш організм можна уявити як відносно ізольовану систему, між якою та навколишнім середовищем відбувається обмін речовин та енергії (іл. 17). Травна система забезпечує організм
для побудови складників, частина розщеплюється з вивільненням енергії для забезпечення протікання різноманітних процесів. Дихальна система постачає потрібний для цього
влює утворення внутрішнього
вища, у якому функціонують усі
людини. Поняття гомеостазу. Клітини оточені міжклітинною речовиною, проте
клітинами та міжклітинною
17. Організм як

Іл. 18. Утворення міжклітинної речовини

позначено основні складники (іл. 19). Регульований або гомеостатичний параметр це значення певного показника функціонування організму, яке має підтримуватися на визначеному рівні. Рецептор спеціалізована структура, яка здатна сприймати значення цього параметра. Виконувальна структура м’яз або залоза,
регульованого параметра. Для пояснення наведемо опис терморегуляції в організмі. Прикладом параметра нам послугує температура тіла, яка є важливим чинником, адже від неї залежить
реакцій (іл. 20). Чутливі
теплоти:
асинхронно скорочуватися м’язи, ми тремтимо. Під час підвищення температури тіла (певно кожен це
запускаються реакції, направлені на її зниження: інтенсивне виділення поту, що, випаровуючись, забирає надлишкову теплоту.
наступних параграфах ми розглянемо три способи забезпечення
гомеостазу: нервовий, гуморальний та імунний.


Функціонування нервової системи
ляцію організму, що здійснюється шляхом передавання між клітинами нервових імпульсів, які мають електричну природу. Будова нейронів. Нервові клітини —
тіло та відростки (іл. 21). Тіло є основною частиною клітини, де розташовані ядро та інші клітинні структури. Відростки одного типу дендрити слугують для сприйняття подразнень подразників як із навколишнього середовища, так і від інших клітин. Від тіла відходить аксон, яким нервовий імпульс
синапсу. Для



нервового закінчення, приводить до вивільнення вмісту цих пухирців у синаптичну щілину. Дифузією нейромедіатор досягає постсинаптичної мембрани. Її основними білковими складниками є молекули-рецептори, чутливі до нейромедіатора, а також йонні канали, здатні генерувати на постсинаптичній мембрані електричні коливання. На відміну від нервового імпульсу, який поширюється аксонами та завжди є проявом збудження, на постсинаптичній мембрані може виникати як збудження, так і гальмування. Останнє проявляється як ускладнення виникнення на постсинаптичному нейроні нервового імпульсу. Гальмування відіграє важливу роль у нервовій діяльності. Зокрема, воно потрібно аби «вимкнути» непотрібні для здійснення певних рухів м’язи. Нестача гальмування супроводжується розвитком надмірного
що
проявлятися як захворювання, зокрема епілептичний напад. Як нейромедіатори в нервовій системі використовуються десятки речовин. Головним збуджувальним нейромедіатором у мозку є глутамат, головним гальмівним гамма-аміномасляна кислота (ГАМК); на периферії ацетилхолін передає збудження з нервів на скелетні м’язи, а також разом із норадреналіном впливає на роботу внутрішніх органів. Синапси це не просте перемикання
дротів, їхня


Рефлекторний
функцій
Рефлекс це відповідь на подразнення, зумовлена функціонуванням нервової системи. Розрізняють вроджені, або безумовні, рефлекси та набуті, або умовні, рефлекси. Безумовний рефлекс можна розглянути на прикладі простої захисної реакції
руки під час торкання
(іл. 25). На чутливих закінченнях (дендритах) виникають нервові імпульси, які аксонами передаються до спинного мозку. Деякі сенсорні
сприймають параметри
температуру, рівні глюкози або

аналізування інформації, передавання збудження
нейронів до рухових. Деякі такі нейрони можуть
непотрібну активність.
мотонейронів, що керують
відсмикуванню руки. Описана послідовність складників нервової системи «чутливі вставні рухові нейрони» називають рефлекторною дугою. Рефлекторна дуга сукупність складників
які забезпечують регуляцію
сприймають певний параметр
беруть участь у регуляції
раніше,
найшвидші реакції, порівняно


а парасимпатичний — ацетилхоліном. Анатомічні складники
Центральна нервова система (ЦНС) представлена спинним і головним
сенсорних складників
забезпечують надходження інформації
керівних впливів на


вегетативним, маючи на увазі, що він забезпечує ніби
«рослинні» функції живлення, ріст тощо (на відміну від вищих психічних).
Зрозуміло, що забезпечення гомеостазу є головною функцією саме автономної нервової системи. У ній виокремлюють симпатичний і парасимпатичний відділи (іл. 28). У кожному відділі є нейрони двох рівнів. Тіло першого з них передвузлового розташоване в центральній нервовій системі. Його аксон прямує до периферійного нервового вузла (якого немає в соматичній нервовій системі), де міститься тіло другого нейрона. Післявузловий аксон іннервує
«боротьба або втеча» (іл. 27). Її активація посилює реакції, направлені
витрати організмом енергії. Натомість парасимпатична нервова система забезпечує реакції, направлені на накопичення
певної міри вони працюють як антагоністи. Зокрема, симпатична система прискорює серцебиття та гальмує травлення, а парасимпатична навпаки. Проте ця закономірність не абсолютна. Наприклад, обидва відділи стимулюють слиновиділення, але склад

Розширення
Прискорення
Звуження
Розширення Гальмування
Звуження Уповільнення
Звуження
Стимулює жовчовиділення
Активізація
Скорочення
них виділяють 8 шийних, 12 грудних, 5 поперекових, 5 крижових та 1–3 куприкові сегменти (іл. 29). На рівні першого шийного хребця
ходить у головний мозок, а на рівні
хребця переходить у кінцеву нитку.
які виконують захисну функцію. Сегменти спинного

рена переважно
інформацію від спинного мозку до головного, від головного до спинного або між різними сегментами спинного мозку. Вона ділиться сірою речовиною на три канатики: передній, бічний і задній. Ознайомитися з будовою спинного мозку можна за його зображеннями, на яких добре видно сіру та білу речовину, роги сірої речовини та канатики білої речовини (іл. 31).
Сегменти спинного мозку виділяють відповідно до місця виходу корінців. Кожен сегмент дає початок
нервів, які іннервують відповідні частини тіла (іл. 29). Чутливі нейрони отримують інформацію від рецепторів шкіри та м’язів. Мотонейрони іннервують поперечно-посмуговані м’язи тулуба й кінцівок. Руйнування заднього корінця призводить до втрати чутливості
ураження. Руйнування переднього
здатності до рухів
ураження.
Функції
Висхідними шляхами


і регуляції діяльності
ються функціонуванням рефлекторних дуг. У межах спинного мозку замикається багато рефлекторних дуг. Рефлекси, які забезпечу
ються спинним мозком, можна розділити на вісцеральні й соматичні.
До вісцеральних рефлексів спинного
виділення, дефекації, статеві тощо, які регулюються на рівні крижових сегментів. Вони можуть контролюватися вищими відділами нервової системи.
Соматичні рефлекси забезпечують
й кінцівок. До них, зокрема, належать рефлекси розтягнення м’язів, прикладом яких є колінний рефлекс (іл. 32). Для його перевірки по сухожилку під наколінком розслабленої і зігнутої
сять несильний удар молоточком.

розгинання кінцівки (іл. 32).
спинного мозку, зокрема, відображала контакти аксонів чутливих нейронів із великими мотонейронами переднього рогу спинного мозку (іл. 33).
Описана рефлекторна дуга містить всього
синапс
центральної нервової системи. Інші рефлекси можуть бути складнішими, а їхні рефлекторні дуги можуть містити не лише чутливий і руховий, а й один або кілька інтернейронів, як збуджувальних, так і гальмівних. При больовому подразненні кінцівки спостерігаються захисні згинальні або розгинальні рефлекси, приклад якого ми розглянули в попередньому параграфі. Механічне подразнення шкіри призводить до розвитку чухального рефлексу, який направлений на видалення зі шкіри подразника. Варто відмітити, що участь спинного мозку в
організму не обмежується простими рефлекторними реакціями. До його мотонейронів прямують низхідні волокна, якими передаються керівні команди, зокрема про довільні рухи, що ми їх хочемо виконати. Окрім цього, інтернейрони спинного мозку
об’єднання, які забезпечують ритмічне збудження та гальмування мотонейронів м’язів антагоністів, що

повністю.
шований у порожнині черепа (іл. 34). На моделях і зображеннях можна побачити,
мозку вирізняються три основні складники: півкулі кінцевого мозку, на які припадає більша частина
стовбур, який ніби лежить в основі півкуль; мозочок — невелика структура, що нагадує
мозку.
глибині головного мозку існують порожнини, заповнені спинномозковою рідиною — шлуночки
кілька


не всі з них є змішаними: деякі виключно рухові,
Довгастий мозок. Довгастий
є
відділом головного мозку. Як і в інших частинах стовбуру, у ньому виділяють сіру й білу речовину. Сіра речовина формує скупчення ядра, які лежать усередині білої речовини. Ядра сформовані тілами нейронів, а біла речовина їхніми аксонами. Функції довгастого мозку можна об’єднати у дві головні групи. Провідникова функція полягає в проведенні інформації від спинного мозку до вищих відділів головного мозку й у зворотному напрямку. Зрозуміло, що ця функція притаманна й іншим відділам мозку. Рефлекторна функція зумовлена тим, що довгастий мозок забезпечує вегетативні рефлекси, як-от слиновидільний, смоктання, ковтання, захисні (блювотний, кашель, чхання) тощо. Окрім цього, у довгастому мозку містяться дихальний і судиноруховий центри, які беруть участь у регуляції дихання та кров’яного тиску. Травмування головного мозку нижче дихального центру призводить до смерті внаслідок зупинки дихання. Міст. Ядра цього відділу регулюють важливі рефлекси, які можна розподілити на вегетативні й соматичні. До вегетативних рефлексів належать реакції, пов’язані зі слиновиділенням, сльозовиділенням і потовиділенням, а також із жуванням і ковтанням. Важливе значення для організації рухової діяльності мають ґрунтовані на інформації від вестибулярного апарату рефлекси, які забезпечують підтримання рівноваги й положення тіла в просторі.
Іл. 36. Черепні нерви людини та їхні функції І — нюховий, нюх; ІІ — зоровий, зір; ІІІ — окоруховий, рухи очей; IV — блоковий, рухи очей; VI — відвідний, рухи очей; V — трійчастий, іннервує жувальні м’язи, отримує інформацію від шкіри обличчя, слизових оболонок носової і ротової порожнин, а також від лицевих м’язів; VII — лицевий, іннервує м’язи

час виконання дій, уповільнення заміни одного руху на інший. Із часом такі ураження можуть компенсуватися
горбкове тіло, утворене двома парами горбків верхніми


інформації рівні (іл. 39). За умов обмеження потоку збудження від органів чуття ступінь активності ретикулярної формації знижується, відповідно зменшується й рівень активації кори людина засинає. Проміжний мозок. Цей відділ утворений таламусом, гіпоталамусом, епіфізом і гіпофізом. Головною структурою є таламус, нейрони якого мають численні зв’язки з іншими складниками нервової системи: спинним мозком, мозочком, кінцевим мозком тощо. Деякі ядра таламуса виконують перемикальну сенсорну функцію: ними від сенсорних структур до кори великих півкуль прямує вся чутлива інформація, за винятком нюхової (зорова, слухова, тактильна, больова, смакова, вестибулярна) (іл. 40). «Моторні» ядра залучені до регуляції рухів, вони працюють разом із моторною корою, мозочком та основними ядрами кінцевого мозку. Складніші за функціями асоціативні ядра залучені до складних процесів, як-от планування поведінки, переключення між різними стратегіями, прийняття рішень, навчання та формування
пам’яті тощо.
Гіпоталамус є вищим інтегративним центром автоматичних, соматичних і ендокринних функцій,
стазу. Також до проміжного





або базальними. Біла речовина формує
передається від нижче розташованих нервових структур
кори в зворотному напрямку, а також між різними частинами
мозку. Найбільшим утворенням білої речовини є мозолисте тіло, крізь яке обидві півкулі обмінюються більшою частиною інформації. Основні ядра беруть участь у регуляції рухів (разом з моторними ядрами таламуса та чорною речовиною середнього мозку), вони є необхідними для формування моторних навичок і умінь, а також забезпечення процесів уваги. Кора великих півкуль утворює численні складки, формуючи борозни й звивини. Три найбільші борозни центральна, бічна й тім’яно-потилична поділяють кору на чотири частки: лобову, тім’яну, скроневу й потиличну (іл. 41). Частина кори, яка оточує стовбур і
утворює низку структур, що їх разом називають лімбічною системою. До її функцій відносять регуляцію
скроневої частки є важлива структура морський
функціями


яка
результатами програми поведінки. Різні її ділянки мають певну функціональну спеціалізацію (іл. 43). Зокрема, потилична частка містить центральну частину зорової сенсорної системи, скронева частка центр слуху, поруч з яким міститься ділянка, що відповідає за сприйняття усної мови. Тім’яна частка містить центральну частину соматосенсорної системи, до якої надходить тактильна, температурна й больова інформація від усього тіла. Перед нею в лобовій частці розташована моторна кора, яка відповідає за формування збудження, необхідного для здійснення довільних рухів. Воно виникає в уже знайомих вам клітинах Беца й прямує до
частині нижньої лобової звивини розташований центр,
Більша частина тім’яної кори формує асоціативну область. Її нейрони отримують збудження від центральних структур усіх сенсорних систем, що є необхідним для формування цілісної картини світу. Функцією лобових відділів кори є прийняття рішень і програмування поведінки. Детальніше про вищі функції головного мозку ми поговоримо, вивчаючи теми 8 і 9. Варто зауважити, що різні структури нервової системи, описані вище, не працюють повністю автономно. Структури спинного й головного мозку утворюють функціональні об’єднання, необхідні для виконання поточних програм поведінки. Усі відділи нервової системи працюють узгоджено й скоординовано як єдине ціле.
Іл. 43. Функціональна спеціалізація ділянок кори великих півкуль Передцентральна звивина, моторна кора Зацентральна звивина, соматосенсорна кора Слухова кора Слуховий центр мовлення (розпізнавання слів) Зорова кора
Нижня скронева кора, розпізнавання складних образів
Моторний центр мовлення, здатність членороздільно говорити
Термін «гуморальний» не
«рідина». Гуморальна регуляція. Гуморальна регуляція
виділенням ендокринними залозами
іншими клітинами в кров спеціалізованих регуляторних сполук гормонів. Із
досягають чутливих до них органів і впливають
ванні на гормони головна роль належить
торам клітин-мішеней (іл. 44). Дія гормонів є більш відкладеною
навіть години після виділення в
ефекторні, які змінюють функціонування внутрішніх органів;
Ендокринні залози.


втомлюваністю.
цьому
шується в розмірах (горло набуває вигляду вола). Природною причиною цього може бути дефіцит Йоду в їжі й воді, оскільки цей елемент міститься в молекулах тироїдних гормонів. Для профілактики використовують йодовмісні харчові добавки або йодовану сіль. Попередити такий стан
можна вживанням у їжу харчових продуктів, багатих на Йод (іл. 46). Гіпертироз надмірне вироблення гормонів супроводжується збільшенням рівня обмінних процесів, інтенсивності серцевої діяльності, дихання, підвищеною нервовою збудливістю, дратівливістю, втомлюваністю тощо. Кальцитонін бере участь у регуляції концентрації Кальцію, впливаючи на швидкість утворення кісткової тканини. Його дефіцит у людей похилого віку може бути причиною
які
концентрацію Кальцію в крові.



ліпідів і вуглеводів, переважно стимулюючи енергетичний обмін. Вони є важливою ланкою стрес-реагування. Також тут синтезуються статеві гормони. У дорослої людини вони утворюються
вими залозами, проте до статевого дозрівання, а також у старості
надниркових залоз є єдиним джерелом цих гормонів. Головним гормоном мозкової речовини
системну дію, а його ефекти подібні до симпатичних, направлені на підготовку організму до «боротьби або втечі» (іл. 48).
Статеві залози продукують уже згадані статеві гормони андрогени та естрогени необхідні для нормального розвитку
функціонування статевих органів, а також формування
Андрогени є чоловічими статевими
чають розвиток
первинних і вторинних статевих ознак, є необхідними для сперматогенезу. Головним із них є тестостерон. Естрогени (естрадіол, естрон, прогестерон) є жіночими статевими гормонами.
суттєвих змін залежно


гормону призводить до розвитку цукрового діабету. Глюкагон є фізіологічним антагоністом інсуліну, його головна дія направлена на клітини печінки, у яких він стимулює розщеплення глікогену та утворення глюкози (іл. 50).
Епіфіз, або шишкоподібна залоза, частина проміжного мозку, чиї нейрони виробляють мелатонін, який бере участь у формуванні
ритмів.
Крім перелічених, до синтезу гормонів
й інші органи, для яких це не є основною функцією. Так, тимус, або вилочкова залоза, продукує тимозин, який регулює дозрівання певних груп лімфоцитів. Утворювати гормони здатні нирки, печінка, серце, органи травної системи. Можна бачити, що гормони впливають на багато функцій організму. Деякі з них є вузькоспецифічними, впливають на окремі
(інсулін рівень глюкози). Інші є системними, тобто
значну

кування та залучений до закоханості. Описана в попередньому параграфі гуморальна
важливим механізмом підтримки гомеостазу, забезпечення росту та розвитку організму.
в гіпоталамусі,
Нейросекреторні клітини, що синтезують рилізинг-гормони

клітини, що синтезують окситоцин тa вазопресин
зинг-гормони. Їхніми мішенями є клітини передньої частки гіпофізу (іл. 51). Тут рилізинг-гормони впливають на виділення в кров гіпофізарних тропних гормонів, стимулюючи або гальмуючи цей процес. Щоб підкреслити нейрональне походження, рилізинг-гормони, вазопресин та окситоцин називають нейрогормонами. Розглянемо роботу рилізинг-гормонів на прикладі (іл. 52). Одним із цих гормонів є кортиколіберин. Він посилює виділення гіпофізом адренокортикотропного гормону (АКТГ). Своєю чергою, АКТГ контролює роботу надниркових залоз, стимулюючи виділення ними глюкокортикоїдів. Ці гормони є ефекторними. Вони впливають на внутрішні органи, зумовлюючи реакцію
серцебиття тощо.

високі рівні тироїдних гормонів гальмують виділення стимулюючих тироліберину гіпоталамусу та
гормону гіпофізу, відтак рівень гормону стабілізується
також виробляє соматотропний гормон (гормон росту, або СТГ), який стимулює синтез
тканин, а
їх ріст. У випадку недостатнього синтезу цього гормону
карликовість. Якщо ж його кількість є
(іл. 54). У випадку надмірного утворення соматотропного
в дорослої людини стимулюється ріст багатьох м’яких тканин організму, деяких сполучно-тканинних утворень і кісток (пальці
ніс, нижня щелепа, язик тощо). Таке захворювання називають акромегалією.
Не менш важливою є роль
остатичні параметри як-от











нервової системи
на внутрішні органи.
Гіпоталамо-гіпофізарна система. Зважаючи на міцні функціональні зв’язки, говорять про єдину гіпоталамо-гіпофізарну систему нервово-гуморальної регуляції (іл. 55). Саме на рівні цієї системи відбувається взаємодія нервових рефлекторних дуг і реакцій виділення гормонів. Її функціональні порушення можуть супроводжуватися розладами регуляції передньої частки гіпофіза, а відтак розбалансуванням системи залежних від гіпофізу
що
до істотних розладів функціонування всього організму. Для профілактики нервових хвороб та ендокринних розладів слід дотримуватися декількох
спосіб життя, який включає регулярний якісний сон, фізичну активність і збалансоване харчування. Важливо уникати шкідливих звичок, бажано обмежувати стресові
їхній вплив. Є й конкретні рекомендації щодо певних розладів, наприклад уживання достатньої кількості
набиранню надмірної ваги допоможе уникнути
Іл. 55.

лодимир Правдич-Немінський
(1924–2010), молекулярна структура
ім. О. О. Богомольця протон-чутливого іонного каналу (ASIC). Українське товариство
понад 150 науковців із різних наукових установ та університетів нашої країни. Одним із проєктів, який підтримує товариство, є проведення конкурсу з нейронаук поміж школярів і школярок. Його переможці представляють Україну на міжнародному змаганні International Brain Bee, яке підтримується ключовими міжнародними організаціями з вивчення нервової системи. У 2021 році учениця київської школи № 125 Вікторія Виджак виборола в ньому абсолютне
перше місце, до того ж отримавши спеціальний приз за найкращі знання анатомії та гістології! Змагання відбувається англійською — міжнародною мовою науки. Спробуйте свої сили, виконавши тестові
1. What process underlies our ability to learn and remember?
A neuronal generation C synaptic plasticity
B hormonal secretion D cell division

Логотип Українського нейроконкурсу. Він проводиться щороку під час Всесвітнього тижня мозку в березні. Долучайтеся!
2. On a cross-section, the white matter of the spinal cord forms: A funiculi B horns C roots D nerves
3. This small part of the brain is covered by a cortex that forms numerous folds. Its main function is to regulate movements. Name this structure. A hippocampus B thalamus C corpus callosum D cerebellum
Самоконтроль рівня
Тестові завдання з однією відповіддю (0,5 бала)
1. Відповідь на подразнення за участі нервової системи
називають
А таксисом В рефлексом
Б тропізмом Г подразливістю
2. На уроці учень підписав на рисунку
складники нейрону. Який підпис
зроблено ПОМИЛКОВО?
А Ядро
Б Джгутик
В Дендрити
Г Цитоплазма


3. Складник головного мозку, який має поверхню, утворену численними заглибинами і складками, — це
А мозочок В середній мозок
Б проміжний мозок Г довгастий мозок
4. Укажіть залозу, яка керує роботою
А гіпофіз В щитоподібна
Б надниркова Г підшлункова
5. Буквою Х на рисунку позначено
А гіпофіз
Б вилочкову залозу
В надниркову залозу
Г щитоподібну залозу

6. Захворювання, яке виникає внаслідок нестачі гормону росту в молодому віці, — це А акромегалія В цукровий діабет Б карликовість Г Базедова хвороба
Тестові завдання з однією відповіддю (1 бал)
7. У проміжному мозку містяться центри, які А відповідають
9.
наведено в рядку
А 1 вазопресин, 2
Б 1 інсулін, 2
В 1 тироксин, 2 посилення енергетичних процесів
Г 1 паратгормон, 2 підвищення концентрації Кальцію в плазмі крові
Тестові завдання з однією відповіддю (1,5 бала)
10. Два учні на уроці обговорювали наведений рисунок. Перший учень стверджував, що на ньому цифрами 1–2 позначено відділи автономної
нервової системи. Другий зауважив, що функціонування цієї системи не залежить від волі людини. Чи має хтось із них рацію?
А лише перший учень Б лише другий учень
В обидва мають рацію
Г обидва помиляються
11. Проаналізуйте твердження.

І. У гіпоталамусі утворюються деякі гормони, зокрема вазопресин.
ІІ. Вазопресин вивільняється в кров у гіпофізі.
Чи є поміж них правильні?
А правильне лише І
Б правильне лише ІІ
В обидва правильні
Г немає правильних
Тестове завдання з короткою відповіддю (3 бали)
12. Укажіть цифри, якими позначено правильне продовження твердження. Буквою В на рисунку позначено


12. Опорно-рухова
(іл. 56 ). Опорно-рухова система містить кістки й скелетні м’язи. Вона виконує захисну, опорну, рухову, метаболічну, кровотворну й терморегуляційну функції (іл. 58).
Будова кісткової та хрящової тканини. Основою кістки є кісткова тканина, а хряща хрящова тканина. З особливостями будови кісткової та хрящової
здатність
тинну
гелем. Такі клітини називають хондроцитами. Вони часто розташовані



Череп
захищає головний
мозок
У червоному
кістковому
мозку
утворюються складники крові
Грудна клітка
захищає
серце
й легені
Хребет
захищає
спинний
мозок
Тазові кістки
створюють
опору
для внутрішніх
органів
До кісток
кріпляться
м’язи, скорочення яких призводить до рухів
Вивільнення теплоти внаслідок скорочення м’язів
У кістках накопичуються солі Кальцію
та нерви. Клітини внутрішнього шару
чого кістки ростуть і
розміщена під окістям, складена
кутами, формуючи комірки (іл. 59). Виділяють такі типи кісток: трубчасті,
й повітроносні. У трубчастих
розташовані
покриттям компактною.
розміщуються там, де сильні навантаження
вістю, зокрема в надколінку.
участь у
порожнин тіла (грудної, тазової) та виконують захисну функцію. До них належать кістки склепіння черепа, груднина, лопатка тощо.
Змішані кістки мають складну форму. До них належать хребці та кістки основи черепа. Усередині повітроносних кісток є порожнина, вистелена слизовою оболонкою і заповнена повітрям. Вона є в деяких
плоских і змішаних кістках черепа, зокрема лобовій.
Типи з’єднання кісток. Кістки можуть бути з’єднані одна з одною в різний спосіб. Виділяють три типи таких з’єднань: 1) нерухомі коли зміщення між кістками майже не можливі (зокрема шви з’єднання кісток склепіння черепа в дорослих); 2) напіврухомі з’єднання з допомогою хрящового прошарку, за рахунок пружності якого можливі обмежені рухи (міжхребцеві з’єднання); 3) рухомі, або суглобові з’єднання, що забезпечують найбільші за амплітудою рухи. Суглоб (іл. 61) має такі складники: 1) суглобові поверхні двох або більше кісток, укриті хрящем; 2) суглобова сумка (або капсула), що відмежовує суглоб від навколишніх тканин і формує порожнину; 3) суглобова рідина, що заповнює порожнину суглобової сумки, зменшує тертя під час рухів, живить хрящ і забезпечує амортизацію суглоба. За формою виділяють кулясті суглоби (плечовий), циліндричні
Іл. 61. Будова колінного

схожості
і скелет кінцівок.
(іл. 65). Скелет дорослої
скелеті людини
ньощелепна, нижньощелепна,
Іл. 63. Фронтиспіс другого видання книги А. Брема «Життя тварин», 1883

Іл. 64. Будова черепа
лицевого
Лобова
кістка
Носова
кістка
Ключиця
Лопатка
Ребра
Хребці
Тазові
кістки
Стегнова
кістка

Череп

Груднина
Плечова
кістка
Променева
кістка
Ліктьова
кістка
Кисть
Велика
гомілкова
кістка
Мала
гомілкова
кістка
Стопа

кінцівок. Пояс верхніх кінцівок містить лопатки та ключиці. Ключиці з’єднані з грудниною й лопатками.
кожна з яких утворена зростанням трьох інших: лобкової, сідничної та клубової. Тазова кістка
стегновою кульшовий суглоб. Кінцівки людини мають схожий план будови. Складниками верхньої кінцівки є плечова кістка, передпліччя (утворене двома кістками ліктьовою та променевою), і кисть. Кисть містить зап’ясток, п’ясток і фаланги пальців. Складниками нижньої кінцівки є стегнова кістка, гомілка (містить малу та велику гомілкові кістки), і стопа. Стопа містить передплесно, плесно й фаланги пальців. Особливості скелета людини у зв’язку з прямоходінням. Скелет людини має низку особливостей порівняно з тваринами: є вигини хребта, які дозволяють компенсувати вертикальні навантаження, що виникають під час ходіння; тіла
склепіння, яке забезпечує
68. Будова

рухів» (іл. 70). З’ясуймо, як саме забезпечуються рухи
в організмі людини.
Функції скелетних м’язів. Основною функцією скелетних м’язів є забезпечення рухів. М’язам притаманна властивість скорочуватися
зменшуватися в довжині, розвиваючи при цьому зусилля. Скелетні
виконують роботу за принципом
мимовільно асинхронно скорочуватися
теплота, яка виробляється завдяки цьому, з
Скелетні м’язи, зокрема м’язи


помітне чергування світлих і темних ділянок, що визначило назву тканини. Така особливість організації мікрониток зумовлює здатність до сильніших скорочень порівняно з гладенькими м’язами. Ця тканина майже не містить міжклітинної речовини.
Будова скелетного м’яза. Складниками скелетного м’яза є м’язові волокна, зібрані в пучки. Основний об’єм м’язового волокна займають скорочувальні елементи міофібрили, які саме й містять скоротливі білки (іл. 72). Кожен пучок покритий тонкою сполучнотканинною оболонкою. Пучки м’язових волокон утворюють широку частину м’яза черевце. Вони також покриті сполучнотканинними оболонкам над пучками розміщений прошарок пухкої сполучної тканини, поверх якого розташований сполучнотканинний чохол фасція (іл. 72). Фасції відмежовують м’язи один від одного, зменшують тертя під час роботи, підтримують черевце м’яза. З одного боку м’яза пучки волокон приростають до кістки, формуючи головку м’яза, з іншого сполучнотканинні елементи переходять у сухожилки, які кріплять м’яз до іншої кістки. Деякі м’язи утворюють кілька






Класифікація скелетних м’язів. М’язи класифікують за формою (іл. 73), за розташуванням (наприклад, м’язи голови, тулуба, кінцівок), за напрямком волокон (наприклад, прямі, косі, поперечні). За функціями виділяють: згиначі (згинають кінцівки); розгиначі (розгинають їх); стискачі (колові м’язи, які перетискають порожнисті органи); відвідні (відводять кінцівки
самого руху, називають синергістами. М’язи, які здійснюють
рухи, зокрема згинання і розгинання
самого суглоба, називають антагоністами. Групи скелетних
м’язів. М’язи голови поділяють на
склепіння черепа (зміщують шкіру, піднімають брови) та м’язи обличчя

рефлекторні (жування,
Іл.
Потиличний м’яз
Дельтоподібний м’яз
Триголовий
м’яз
плеча
Найширший м’яз
Розгиначі
кисті й пальців
Великий
сідничний м’яз
Двоголовий
м’яз
стегна
Литковий
м’яз
Згиначі кисті й пальців
Коловий м’яз ока
Жувальні м’язи
Дельтоподібний м’яз Двоголовий
Косий
м’яз
живота
Прямий м’яз живота
Кравецький м’яз
Чотириголовий м’яз стегна
фізичних навантажень — ми з вами розглянемо в цьому параграфі. Організм людини здатен до фізичних навантажень завдяки функціонуванню складників опорно-рухової системи, зокрема м’язів.
Функціонування м’язів. Згадаємо, що м’язове волокно утворюється злиттям первинних м’язових клітин. Зовні воно вкрите плазматичною мембраною сарколемою. Під нею розташована саркоплазма (цитоплазма), яка містить, зокрема, ядра й велику кількість мітохондрій. Основний обсяг м’язового
міофібрили, про що ви дізналися з попереднього параграфа
ультрамікроскопічному рівні
лена регулярним розташуванням різних


тонкі, або лише товсті, а також
мікрониток. Міозин здатен зв’язуватися з актином за допомогою поперечних містків, які утворюються його головками. Під час збудження м’язового волокна відбувається просування міозинових мікрониток уздовж актинових, унаслідок чого зменшується довжина саркомера (іл. 76). Скорочення багатьох саркомерів призводить до скорочення довжини всього м’яза, що зумовлює виконання фізичної роботи.
Забезпечення м’яза енергією. Для виконання роботи органам, зокрема й м’язам, необхідна енергія. Згадайте, що органелами клітин, які відповідають за енергетичне забезпечення, є мітохондрії. За участю кисню в мітохондріях поживні речовини розщеплюються з вивільненням енергії. Отже, умовою для функціонування м’язів є постачання їх киснем. У м’язі, що інтенсивно скорочується, кровообіг може збільшуватися у 20 разів, а отже так само збільшується й постачання клітин киснем. Проте інтенсивність утворення енергії в мітохондріях часто все одно недостатня. За такого стану клітини переходять у
режим отримання енергії. Це призводить

виникнення болю («кріпатура»). Помірна м’язова активність підтримує збільшений кровоток і сприяє вимиванню з м’язів молочної кислоти, зменшуючи симптоми «кріпатури». Такий стан
також через мікротравми м’язових волокон у запальний процес. Робота м’язів. Людина виконує різноманітні рухи, пов’язані як із переміщенням тіла в просторі або предметів з певною швидкістю,
Предмет (гантеля) масою 3 кг утримували рукою на рівні плеча,
час,
Дані записували в колонку таблиці «Статична робота».
2. Після відпочинку (до 5 хв) ту саму
скали. Помічали час, за який настала втома.
«Динамічна робота».
з підтримання постави характеризується меншими затратами енергії і може тривати довгий час. Статична робота, яка пов’язана із утриманням предметів, є більш втомливою, оскільки постійне напруження однієї і тієї ж м’язової групи супроводжується зменшенням у ній кровообігу, що внеможливлює своєчасне виведення продуктів розщеплення. Під час динамічної роботи почергово змінюється напруження різних м’язів, що уможливлює відновлення їхньої працездатності. Основною причиною втоми скелетних м’язів є виснаження нервових центрів, які регулюють роботу м’язів. Рухова активність. Рухова активність спричиняє
енергії, а відтак сприяє підтриманню енергетичного балансу організму й запобігає розвиткові надмірної ваги. Низький рівень рухової активності називають гіподинамією
тренувань, зрозуміло, є збільшення розмірів, сили та витривалості скелетних м’язів. Рухова активність також покращує функціональний стан серцево-судинної та дихальної систем, покращує роботу ендокринної та імунної систем, зміцнює кістки, підвищує опірність організму людини до інфекційних захворювань. Вона сприяє нормалізації обміну речовин, покращує настрій та психічне здоров’я.

§ 16. Ушкодження опорно-рухової системи. Порушення постави
Сучасна медицина вможливлює
життя навіть у разі суттєвих ушкоджень органів. Це зумовлено, зокрема, розвитком 3Dтехнологій. Україна 2022 року підписала з корпорацією A.D.A.M. (США) меморандум про співпрацю щодо розроблення, підтримки та втілення проєктів із 3Dдруку імплантів кісток та інших частин тіла для лікування військових та цивільних українців. Які ушкодження кісток відомі? У разі дії на організм механічних чинників надмірної
відбуватися травми опорно-рухової системи.
мування тканин і органів без порушення
спричиняє
руйнування деяких клітин і дрібних кровоносних судин удар супроводжується болем, посинінням
тканин.
прикладання до неї охолоджувального
інтенсивності може викликати розтягнення
що супроводжується ускладненням
тугу


до його подальшого травмування, тому
Переломи кісток пов’язані з
їхньої цілісності (іл. 79, б). У разі відкритих переломів уламки кісток проривають шкіру, закритих шкіра залишається цілою. Ознаками перелому є неприродне положення кістки, припухлість і різкий біль. У разі відкритого перелому необхідно
зупинити кровотечу, накласти стерильну пов’язку на рану, а потім знерухомити кінцівку. При закритому переломі знерухомлення кінцівки є першочерговим заходом. Варто зазначити, що у випадку всіх описаних травм необхідно обов’язково звернутися до лікаря. Спроба самостійного лікування може призвести до подальшого травмування організму. Порушення постави. Деякі проблеми опорно-рухової системи можуть розвиватися без зовнішніх впливів. Зокрема, часто трапляються порушення постави. Ви вже знаєте, що лордоз та
є
вигинами хребта. Їхнє посилення або згладжування може бути ознакою порушення постави. У випадку скривлення хребта вправо або вліво виникає сколіоз. Для профілактики порушень хребта необхідно зберігати правильне положення тіла під час сидіння за столом, правильно носити важкі предмети тощо (іл. 80). Поширеною формою порушення скелета є плоскостопість сплощення склепіння стопи (іл. 81). Воно супроводжується болем



нервовій
симпатичного й парасимпатичного відділів, а також як кінцевий нейромедіатор парасимпатичних післявузлових нейронів. Постсинаптична мембрана сприймає АХ за допомогою ацетилхолінових рецепторів, які бувають кількох типів. Одні з них називають нікотиновими, оскільки вони активуються, окрім АХ, біологічно активною сполукою нікотином, що міститься, зокрема, у тютюні. Чимало відомостей про нікотинові холінорецептори здобули українські вчені. Зокрема, академік Володимир Іванович

(1932–2003) уперше
синаптичної передачі може позначитися на функціонуванні як симпатичної так і парасимпатичної нервової системи.
Самоконтроль рівня
Тестові завдання
1. Укажіть одну з функцій опорно-рухової системи людини.
А видільна
Б регуляторна
В транспортна Г кровотворна
2. Одним зі складників кісткової тканини є А еритроцит В нейрон Б остеоцит Г міоцит
3. На рисунку м’язову тканину позначено





4. Укажіть тип з’єднання стегнової
А напіврухоме В суглоб Б зростання Г шов
5. Укажіть кістку скелета, яка захищає
А стегнова В плечова Б ключиця Г лобова
6. Які складники безпосередньо
м’язових волокон?
А актин і міозин Б ядро й мітохондрії
7. Проаналізуйте

8. ПОМИЛКОВОЮ
А знезараження
Б знерухомлення травмованої
9. Гіподинамія призводить до
А підвищення рівня
В збільшення сили скорочення серцевого м’яза Г зниження опірності інфекційним захворюванням
Тестові завдання з однією відповіддю
10. Два учні на уроці обговорювали особливості скелета людини. Перший учень стверджував, що
Г обидва помиляються
11. Правильне твердження щодо функціонування скелетних
дено в рядку
А під час ритмічного скорочення
енергії
В основною
центрів
12. Укажіть кістки,
1 стегнова 2 груднина
3 променева

або метаболізмом. В організмі одночасно відбуваються процеси двох типів.
утворення речовин, необхідних для життєдіяльності організму,
лишнього середовища надходять певні сполуки. При цьому поглинається енергія, необхідна для утворення хімічних зв’язків. Сукупність реакцій утворення (синтезу) складних речовин із простих, під час яких енергія поглинається, називають пластичним обміном,
Цей процес забезпечує розвиток
розщеплення речовин.
речовин
що вивільняється
впорядковано за участю ферментів. Завдяки їм реакції йдуть швидко й
тивно за звичайних умов функціонування клітин. Перетворення енергії. Для забезпечення власних енергетичних потреб організми використовують енергію, що надходить із навколишнього середовища. Вони акумулюють енергію у формі хімічних зв’язків органічних молекул, отже, перетворення енергії взаємопов’язане з обміном речовин.
Згадайте, що організми, які використовують енергію готових органічних речовин, називають гетеротрофами. До цієї групи належать більшість бактерій, гриби та тварини (іл. 83), зокрема й людина. Для них джерелом енергії є синтезовані іншими організмами органічні сполуки, які вони одержують із їжею. Енергія, що надходить до організму, може запасатися в хімічних зв’язках синтезованих сполук або ж витрачатися на різноманітні процеси функціонування. Витрачена енергія перетворюється на теплову. Живим системам притаманний енергетичний баланс:
отримує, стільки
принцип
Іл. 83. Гетеротрофні



руйнуються. В організмі постійно відбувається заміна «старих» білків на «нові». Частина
що надійшли з їжею, частина з амінокислот, утворених унаслідок розщеплення «старих» білків. Амінокислоти їжі використовуються переважно для пластичних потреб і відіграють
складу


ному тракті, перетворюється в клітинах печінки на глікоген. Певна кількість глікогену також є у волокнах скелетних м’язів та гліальних клітинах нервової тканини. Речовини однієї хімічної природи можуть перетворюватися на речовини іншої хімічної природи. За нестачі вуглеводів вони можуть синтезуватися з жирів або амінокислот. У результаті надлишкового споживання вуглеводів вони можуть перетворюватися на жири й депонуватися в жировій тканині організму. Обмін ліпідів. Ліпіди, зокрема жири, які надходять з їжею (іл. 85), розщеплюються до моногліцеридів і жирних кислот. Вони надходять до ентероцитів, у яких відбувається синтез власних видоспецифічних ліпідів. Ці ліпіди транспортуються до лімфатичних капілярів, з яких у складі лімфатичної системи переносяться до печінки. Там відбувається утворення складних білків, що з током лімфи надходять у
якою розносяться до клітин. Надлишок жирів
депонуватися в жировій тканині. У разі потреби жири можуть розщеплюватися з отриманням енергії, причому енергетичний
(іл. 86).
речовин є їжа. Загальний план будови. Сукупність процесів,
на розщеплення складних
речовин їжі до простих, називають травленням. Воно відбувається в органах, які об’єднані в травну систему. Ця система забезпечує механічне подрібнення їжі, ферментативне розщеплення сполук та всмоктування продуктів розщеплення. Травна система людини містить травний тракт у формі трубки, а також травні залози. Травний тракт починається з ротової порожнини, яка переходить у глотку. Далі знаходиться стравохід, за яким розміщений шлунок, після якого
ляють тонку й товсту кишки. Закінчується кишечник прямою
з анальним отвором (відхідником). До травних
межами травної трубки, відносять
Усередині ротової порожнини є великий м’язовий орган язик. Його поверхня утворена епітелієм зі смаковими рецепторами. За участі язика й зубів здійснюється механічна обробка їжі та ковтання. Зуби — це кісткові утворення, занурені в порожнини щелеп. Щелепи вкриті слизовою оболонкою — яснами. Частину зуба, що видається в ротову порожнину, називають коронкою. Іншу частину, розміщену в щелепі, називають коренями. Основна частина зуба утворена дентином. Під ним у коренях є канали, які в коронці розширюються в порожнину, де є кровоносні судини й нервові волокна. Це пульпа. Зовні зуб оточений емаллю на коронці й цементом на коренях (іл. 88). У дорослої людини є чотири типи
різці (центральні зуби у формі пласких пластинок); ікла (мають гостру форму); малі кутні (мають
пласку поверхню); великі кутні (мають коронку великого розміру). Різці
відіграють основну роль у відкушуванні шматочків їжі, натомість кутні зуби у її пережовуванні. Розташування зубів на обох щелепах, а також на двох симетричних половинах кожної щелепи
народження в дитини прорізуються тимчасові, або молочні,
знезаражувальний фермент лізоцим; муцин — білок, що є основою формування слизу. Щоб зрозуміти вплив
речовин їжі,
і виконайте
грудка просувається
акт ковтання. Надгортанник (еластичний
вхід до гортані,
до стравоходу. Травлення в шлунку. Зі стравоходу харчова
шлунка (іл. 90). Внутрішній
шлунка представлений слизовою





ненню їжі до стравоходу й неконтрольованому просуванню шлункового вмісту до дванадцятипалої кишки. Обробка їжі, яка здійснюється в шлунку, відбувається частково завдяки впливу ферментів слини, а здебільшого під дією ферментів шлункового соку. Робота ферментів слини триває до просякнення харчової грудки шлунковим соком, який інактивує їх через високу кислотність. Подрібнена їжа, перемішана із секретами травної системи, називається хімус. Регуляція шлункової секреції відбувається гуморальним і нервовим шляхом. Симпатична автономна нервова система гальмує, а парасимпатична активує секреторну й моторну активність шлунку. Надалі оброблення їжі здійснюється кількома ферментами, головним із яких є пепсин. Він здійснює розщеплення білків. Ферменти шлункового соку працюють у кислому середовищі. Окрім пепсину, у складі шлункового соку є й інші ферменти, зокрема шлункова ліпаза, яка здійснює розщеплення ліпідів. Хлоридна кислота виконує декілька функцій: сприяє розщепленню білків їжі, полегшуючи
сприяє перетворенню пепсиногенів у пепсин; створює кисле середовище, необхідне для функціонування ферментів; знешкоджує хвороботворні організми, які можуть потрапити до шлунка з їжею. Слиз необхідний
для захисту слизової оболонки від пошкоджень і перетравлення.
Іл. 90. Будова шлунка Стравохід
Кардіальна частина Воротар
Воротарний сфінктер Дванадцятипала
виділяють внутрішньосекреторну
(екзокринну) частини. Внутрішньосекреторна
острівцями Лангерганса, клітини яких синтезують гормони
канальців, у які
їжа. Основними ферментами є трипсин і хімотрипсин, які розщеплюють білки. Також підшлунковий сік містить ферменти, що розщеплюють вуглеводи й ліпіди. Секреція залози регулюється нервовим шляхом за допомогою парасимпатичних нервів, що посилюють секрецію та симпатичних нервів, що її гальмують. Печінка. Печінка це найбільша залоза організму людини (іл. 92). Її функція пов’язана не лише з травленням, а й із процесами регуляції обміну речовин. У печінці є велика кількість печінкових пластинок, кожна з яких складається з
печінкових клітин (гепатоцитів). Вони продукують жовч, яка по канальцях збирається в загальну печінкову протоку. Від неї відгалужується міхурова протока жовчного міхура, у якому
разом із загальною печінковою утворюють
виходить із печінки, зливається
разом відкриваються у дванадцятипалу кишку.
Жовч це рідина жовто-коричневого кольору, яка має лужну реакцію. Основним її складником є жовчні кислоти. Вони
участь в емульгації жирів. Жовчовиділення активується парасимпатичною, а гальмується симпатичною нервовою


дять пучки гладеньких м’язів, кровоносні та лімфатичні капіляри. Слизова оболонка містить секреторні клітини. Вони виробляють
містить травні ферменти. Характерною
ентероцитів є наявність на їхній поверхні великої
кості мікроворсинок. Мікроворсинки це
рани цих клітин. На поверхні мікроворсинок
Сукупність процесів травлення, які відбуваються
участі
із мембранами клітин ферментів, називають мембранним травленням. Ці ферменти здійснюють остаточне розщеплення речовин
складників. Зокрема, білки розщеплюються
глюкози. Продукти, які утворилися після розщеплення, усмоктуються з порожнини тонкої кишки до внутрішнього середовища організму. Амінокислоти й глюкоза всмоктуються в кров. Продукти розщеплення ліпідів моногліцериди

не відіграє суттєвої
вання води з хімусу, його ущільнення і формування з неперетравлених решток калових мас. Порожнина товстої кишки заселена симбіонтними
запобігають заселенню порожнини кишечника хвороботворними мікроорганізмами. Також вони синтезують деякі корисні речовини, зокрема вітаміни групи B й К. Кишкові бактерії здатні розщеплювати речовини, які не розщеплюються ферментами травного тракту,
целюлозу. Калові маси виводяться з організму
рефлекторного акту дефекації. Стимулом
кишці. Центр
мозку. Під його впливом
сфінктера й посилюється перистальтика кишки.
буває під гальмівним контролем
для забезпечення пристосувальної поведінки. Іл. 94. Будова

Так, моряки
час довгих подорожей, не маючи
своєму
(аміном життя).
Властивості вітамінів. Вітаміни
гічно активні речовини різної хімічної
рахіту (іл.
компонентів їжі. Усі групи харчових продуктів багаті на вітаміни, проте жоден продукт не може повністю задовольнити потреби організму (іл. 96). Інколи в рослинних клітинах виробляються їхні попередники провітаміни, які перетворюються у вітаміни в організмі. Деякі вітаміни, зокрема K й H, синтезуються кишковою мікрофлорою, а вітамін D утворюється
в шкірі під впливом ультрафіолетового випромінювання. Біологічна роль вітамінів. Біологічна роль вітамінів у різних організмах подібна, але особливу увагу ми приділимо функціонуванню їх
в організмі людини. Сучасні дослідження свідчать про різноманітну участь вітамінів у процесах життєдіяльності організму. Функціонування деяких ферментів залежить від наявності додаткових речовин небілкової природи. Сполуки, необхідні для роботи ферментів, називають коферментами. Ними можуть бути похідні вітамінів, наприклад вітаміни груп B й K.
Вітаміни беруть участь в утворенні деяких гормонів біологічно активних сполук, які регулюють різні етапи обміну речовин в організмі. Наприклад, вітамін D впливає на процеси, що забезпечують утворення і функціонування стероїдних гормонів (статевих, кортикостероїдів).
Іл. 96. Головні джерела деяких вітамінів у харчових продуктах Назва вітаміну Харчовий продукт
B1 (тіамін)
B6 (піридоксин)
Нежирне м’ясо, зернові, бобові,
шпинат
B12 (ціанокобаламін) Печінка, м’ясо, риба, молочні продукти, яйця, морська капуста
C (аскорбінова
A (ретинол)
D (кальциферол)
тощо. Від рівня забезпеченості їжі вітамінами залежить рівень розумової та фізичної працездатності, стійкість людини до впливу несприятливих чинників зовнішнього середовища.
ступеня забезпеченості організму
міноз (відсутність), гіповітаміноз (нестача) та гіпервітаміноз (надлишок). Дефіцит може виникати через неспроможність
клітинами організму. Причинами

жовчі, що перешкоджає всмоктуванню жиророзчинних
мікрофлори тощо. Вітамінна недостатність також
лідок зменшення надходження вітамінів з їжею, недотримання правил кулінарного оброблення та зберігання харчових продуктів (іл. 98).
Ми опишемо деякі захворювання людини, що виникають унаслідок нестачі вітамінів. Бері-бері хвороба, яка вражає нервову систему людини, призводить до слабкості, втрати апетиту, підвищеної збудливості і паралічу, пов’язана з нестачею вітаміну В1. За відсутності в харчових продуктах вітаміну С в людини порушується синтез колагену, що призводить до уповільнення росту сполучної тканини, поганого загоєння ран, кровоточивості ясен, анемії; збільшується схильність до інфекційних захворювань це прояви цинги. Нестача вітаміну А спричинює захворювання, унаслідок якого людина не може бачити в умовах недостатньої освітленості, гемералопію, або «курячу сліпоту». При більш тривалому дефіциті вітаміну А в людини розвивається хвороба ксерофтальмія, яка характеризується сухістю рогівки ока. Нестача вітаміну D викликає в дітей рахіт, за якого порушується мінералізація кісток, затримується розвиток зубів. Вітамін Е сприяє розвитку репродуктивної системи, а тому внаслідок
в чоловіків порушується утворення сперматозоїдів, а в жінок можуть спостерігатися відхилення в розвитку плоду. Вітамін K бере участь у
крові, сприяє зміцненню капілярів.
нестача цього вітаміну може призвести до порушення зсідання
лідок травмування, відкритих переломів тощо.
Іл. 98. Правила оброблення та
з властивостями вітамінів
1. Вітаміни (особливо В1, С) руйнуються внаслідок надто тривалої термічної обробки або надто високої температури.
2. Ферменти розщеплення вітамінів малоактивні за низьких температур.
3. Поміж вітамінів багато водорозчинних.
4. Вітаміни А, В2, В6, В12, С швидко руйнуються
5. Вітаміни А, Е, С легко окиснюються.
А Зберігати в непрозорих контейнерах. Б Овочі та фрукти нарізати не дрібно, зберігати недовго. Поміщати в
контейнери або обгортати плівкою.
Видатні
харчування. Зокрема, американський політичний
жамін Франклін стверджував: «Якщо хочеш
життя, скороти свої трапези». Організм людини є біологічною системою, яка використовує енергію готових органічних речовин, отримуючи їх із їжею. Тому
важливим чинником, що впливає на здоров’я людини, є харчування. Знання щодо раціонального харчування стануть підґрунтям для збереження здоров’я
метаболізму (іл. 99).




шення енергії, що надходить до організму з їжею,
енергії, що витрачається внаслідок його діяльності. Це забезпечує підтримання оптимальної ваги та її стабільність, особливо в дорослому віці. Енергетичну цінність або калорійність органічних речовин визначають за тим, скільки енергії вивільнюється під час розщеплення одиниці маси. Одиницею вимірювання енергії є джоуль або калорія (1 кал = 4,18 Дж). Енергетичну цінність речовин зазвичай визначають, розраховуючи, скільки кілоджоулів або кілокалорій припадає на 1 г речовини. Енергетична цінність жирів 38,9 кДж/г, білків 17,2 кДж/г, вуглеводів 17,6 кДж/г. Можна визначити енергетичну цінність харчового продукту, знаючи його масу та
у 100 г цього продукту (іл. 100). Організм людини витрачає енергію (загальний обмін) на забезпечення життєдіяльності в умовах спокою
активність (функціональний обмін). Загальний обмін підлітка зазвичай становить 170–250 кДж на 1 кг маси тіла за добу. Основний обмін найменша кількість енергії, яку організм
спокою для підтримування
(роботу печінки, нирок, серця, нервової та дихальної систем).
Іл. 100. Визначення енергетичної цінності продукту
— 3,7 г жирів
Іл. 101. Залежність енерговитрат

1:1:4. Необхідно дотримуватися правильного режиму харчування.
чотириразове харчування: перший сніданок 25 % калорійності їжі,
сніданок 15 %, обід 35 %, вечеря 25 % (іл. 102). У їжі мають
бути достатньо різноманітною.
значення має наявність рослинної клітковини (целюлози)
нові продукти. М’ясо містить значну
білків, а риба корисні жири. Разом з цим потрібно уникати надто жирних продуктів, а також обробленого м’яса (копченості). Звісно ж, продукти мають бути свіжими, придатними до споживання, не містити шкідливих сполук, а їжу треба готувати з дотриманням технології кулінарного оброблення. Виконання цих простих правил робить життя людини довшим, що доведено науковими дослідженнями.
Значення води. Необхідно споживати достатньо води, уникаючи
солодких напоїв і значної кількості соків, молока. Як розчинник, вода є середовищем для перебігу багатьох хімічних реакцій в організмі людини. Окрім того, вона може сама вступати в певні реакції
утворюватися як продукт їх перебігу. Завдяки добрій
бере участь у їх транспортуванні. Вона забезпечує пружність
і частин тіла. Завдяки воді послаблюється тертя між різними поверхнями, зокрема в суглобах. Вода має порівняно високі питому теплоємність і теплоту випаровування, унаслідок чого виконує терморегуляторну функцію. Вона переносить теплоту
нагрітих органів до холодніших. Добова потреба у воді залежить від маси тіла (іл. 103). Недостатнє споживання води призводить
Кожен орган шлунково-кишкового тракту може зазнавати патологічних змін унаслідок різних чинників. Запалення. У людини часто трапляються ураження зубів. Карієс порушення цілісності оболонок зуба та розм’якшення його внутрішніх шарів. Унаслідок усередину зуба можуть потрапляти мікроорганізми, що спричиняють запалення. Якщо
до повної втрати
рота стоматит робить
бути неправильне харчування, тютюнопаління, бактеріальні
нервово-емоційне перенапруження тощо. Подібні розлади
виникати й унаслідок запалення
травної системи дванадцятипалої
(ентерит), товстої кишки (коліт), підшлункової залози (панкреатит) або жовчного міхура (холецистит). За певних умов можуть розвинутися порушення цілісності слизової оболонки шлунка або кишки виразка.
Іл. 104. Гумористична карикатура, журнал «Панч», 1858 р.

Іл. 105. Вигляд слизової оболонки шлунка за допомогою ендоскопії:

зана з гострими інфекціями. Гепатит є небезпечним інфекційним захворюванням печінки, за якого відбувається загибель частини її клітин. Причиною його розвитку є віруси. Під час руйнування клітин печінки порушується її функціонування. За такого ураження печінки може відбуватися переродження її тканини на сполучну цироз. Перитоніт
запалення очеревини, що може розвиватися як ускладнення внаслідок
запалення інших відділів травної системи, зокрема апендикса. Апендицит запалення червоподібного відростка товстої кишки. Також
поширені бактеріальні інфекції (іл. 106). Дизентерія гостра інфекція, викликана бактеріями або дизентерійною амебою, які мешкають переважно в товстій кишці. Ботулізм гостра інфекційна хвороба, що характеризується ураженням нервової системи й може призвести до смерті людини. Дуже небезпечним для людини є сальмонельоз. Причиною розвитку холери є бактерія холерний вібріон. Ця хвороба супроводжується розладами травлення, порушенням усмоктування води в товстій кишці та, як наслідок, зневодненням організму. Окрім бактерій, причинами шлунково-кишкових розладів можуть бути інвазії паразитичними безхребетними тваринами, зокрема
Інфіковані продукти, зокрема молоко, вода, предмети хворого
Інфіковані м’ясні продукти, овочеві й рибні консерви, ковбаси, солона та копчена риба
Хворі й бактеріоносні тварини та люди, інфі-
Аналізуємо інформацію, робимо висновки Ознайомтеся з інформацією та виконайте завдання.
Генетично модифіковані організми (ГМО) — організми, які мають штучно змінену спадкову інформацію, тобто гени, модифіковані за допомогою методів генетичної інженерії.

Уперше було створено модифіковану бактерію у 1973 році, тварину — у 1974, рослину — у 1983. За допомогою генетично модифікованих бактерій продукуються необхідний для лікування діабету інсулін, гормон росту, інтерферони та інші важливі для медицини сполуки. Генетично модифіковані рослини використовуються, зокрема, для виготовлення харчових продуктів. У світі вирощують генетично модифіковану сою, ріпак, кукурудзу тощо. Усі вони проходять чимало
шляху до
аналізування наведеної інформації?
А Гени, що містяться в харчових продуктах, можуть ставати генами людини, яка з’їла продукти, що містять ГМО.
Б На сучасному етапі розвитку науки людство відмовилось від використання ГМО.
В За допомогою генетично модифікованих рослин отримують інсулін і гормон росту.
Г Першим генетично модифікованим
Самоконтроль рівня
Тестові завдання з однією відповіддю (0,5 бала)
1. Фермент, який забезпечує розщеплення жирів, це А трипсин В пепсин Б амілаза Г ліпаза
2. Який орган травної системи позначено на рисунку буквою Х?
А шлунок
Б печінка
В товста кишка
Г підшлункова залоза
3. Наслідком нестачі вітаміну
А порушення скорочення м’язів Б порушення сутінкового зору В виведення Кальцію з кісток
Г розвиток ботулізму


4. Вітамін, який у великій кількості міститься в шипшині, цитрусових, капусті, позначено буквою
А D В С
Б В2 Г А
5. Інфекційне захворювання, спричинене одноклітинним евкаріотичним організмом, це — А холера В ботулізм Б гастрит Г дизентерія
6. Укажіть захворювання, яке виникає за нестачі вітаміну. А рахіт В дизентерія Б поліомієліт Г ендемічний зоб
Тестові завдання з однією відповіддю (1 бал)
7. Прочитайте речення: «Білки починають розщеплюватися в (1) під дією (2).» Правильний варіант пропущених слів (1–2) наведено в рядку А 1 ротовій порожнині,
9.

харчових продуктів, яка пов’язана з описаною властивістю вітамінів. А овочі та фрукти необхідно
11. Учень й учениця обговорюва-
фруктів, уміст речовин у яких наведено. Учень зазначив, що найбільшу енергетичну цінність має інжир, який містить більше жирів і білків. Учениця
зазначила, що найменшу енергетичну цінність має виноград.
Чи має хтось із них рацію?
А лише учень
Б лише учениця
В обоє мають рацію Г обоє помиляються


крові. Функції крові. Кров циркулює замкненими судинами
рахунок тиску, що його створює серце. Основною функцією крові є транспортна. Отже, нею транспортуються різноманітні речовини (іл. 107). Відповідно до біологічної функції речовин, які транспортуються кров’ю, можна виділити додаткові функції, що є наслідком транспортної. Зокрема, унаслідок транспортування клітин імунної системи та
виконує захисну функцію. Особливим типом захисної функції крові є запобігання крововтратам. Регуляторна функція крові пов’язана з транспортуванням гормонів (іл. 107).
в тому, що сталість параметрів

Забезпечує захисну реакцію від
перенесення О2 від легень до тканин i CO2 від тканин до легень перенесення поживних речовин від кишечника до тканин
перенесення продуктів метаболізму від тканин до нирок
підтриманні гомеостазу
підтриманні сталої температури інфекцій
гуморальній регуляції
втрати крові під час ушкодження
білки, ліпіди, глюкоза, органічні кислоти, сечовина тощо. Поміж білків крові виділяють дві основні групи: альбуміни, що здебільшого виконують транспортну функцію, та глобуліни, які забезпечують захисні функції (імуноглобуліни, або антитіла), а також беруть участь у зсіданні крові (фібриноген). Плазма крові, позбавлена фібриногену, втрачає здатність до зсідання і називається сироватка (іл. 108). Для нормальної життєдіяльності організму важливе значення мають деякі фізико-хімічні параметри крові. В’язкість крові перевищує в’язкість води в 5 разів. Якщо з плазми видалити фібриноген, то в’язкість отриманого розчину (сироватки) буде приблизно такою самою, як у води. Це означає, що більша частина в’язкості крові зумовлена наявністю формених елементів, поміж яких вирізняють еритроцити, лейкоцити й тромбоцити (іл. 108). Збільшення кількості еритроцитів у крові призводить до підвищення в’язкості крові, що ускладнює її рух судинами. Відносна густина крові також перевищує відносну густину води. Кислотність крові (pH) є одним із найважливіших гомеостатичних параметрів. За нормальних умов цей показник становить 7,35–7,45. Відхилення його на 0,2–0,3 призводить до змін, несумісних із життям. Це пояснюється тим, що відхилення pH від норми змінює структуру більшості білків організму, що внеможливлює
виконання ними своїх функцій.



в організмі людини (іл. 109). Зміст параграфа допоможе вам зрозуміти причини такої кількості
кількість цих клітин відновлюється



кисню до гемоглобіну й утворення оксигемоглобіну. Натомість у капілярах великого кола кровообігу (див. параграф 27) оксигемоглобін віддає кисень (іл. 111). На відміну від кисню, який транспортується переважно у зв’язаному з гемоглобіном стані, вуглекислий газ може переноситися від тканин до легень різними способами. Переважна кількість вуглекислого газу транспортується плазмою крові (62 %) або всередині еритроцитів (27 %). Частина ж вуглекислого
(11 %). Сполуку CO2 з гемоглобіном називають карбгемоглобіном. Окрім кисню й вуглекислого газу, гемоглобін може
(CO), причому утворений
нанням кисню. Утворена сполука
чення частини гемоглобіну
кров використовують для переливання, донором. Проте кров




Ландштайнер отримав Нобелівську премію в галузі
цини за дослідження цього явища
A, так і аглютиногени B, у
аглютиніни α та β; A (II) на еритроцитах містяться аглютиногени A, у плазмі містяться аглютиніни β; B (III)
B,












правила переливання крові (іл. 113). Окрім описаної системи груп крові AB0, існують й інші. Другою за значимістю системою є система резус. За наявністю або відсутністю на еритроцитах резус-фактора (аглютиногена білкової природи) у цій системі виділяють дві групи крові резус-позитивну Rh (+) та резуснегативну Rh (–). На відміну від системи AB0, антитіла до резус-фактора відсутні
лише за повторного вливання резус-позитивної крові в резус-негативну. Сумісність за цією групою має особливе
не змішується. Отже, якщо резус-негативна жінка виношує резус-позитивну дитину, то антитіла до резус-фактора (який присутній у крові плода) в жіночому організмі не виробляються. Проте під час пологів може відбутися часткове змішування крові, що зумовить вироблення імунною системою жінки антитіл до чужорідного
такому випадку повторна вагітність резус-позитивним плодом може перебігати з ускладненнями: антитіла плазми крові жінки, проникаючи крізь плацентарний бар’єр, можуть руйнувати еритроцити плода, що може призвести до його загибелі. Таке явище має назву резус-конфлікт.
Іл. 113. Групи крові
Еритроцити








увів у тіло прозорої личинки шпичку троянди й через деякий час побачив, що амебоцити скупчилися навколо неї. Клітини поглинали чужорідні тіла, які потрапили до організму. Ці клітини він назвав фагоцитами, а саме явище — фагоцитозом (іл. 114). Такі властивості притаманні й деяким клітинам крові людини (іл. 115). Лейкоцити. Лейкоцити це безбарвні клітини крові, які мають ядро, здатні до амебоїдного руху й фагоцитозу. Їхня кількість у


називають гранулоцитами. Вони, у свою чергу, поділяються на
залежно від того, якими барвниками забарвлюються
гранули: лише кислими (еозинофіли), лише лужними (базофіли) чи обома (нейтрофіли). Лейкоцити, які не містять гранул, називають агранулоцитами. Поміж них розрізняють лімфоцити й моноцити. Кількісне співвідношення лейкоцитів різних типів, характерне для крові здорового дорослого організму людини, наведено в таблиці (іл. 116). Таке співвідношення називають лейкоцитарною формулою. Її порушення може бути наслідком розвитку різних хвороб. Зазвичай такий перерозподіл відбувається не за рахунок утворення нових лейкоцитів, а внаслідок виходу в кров’яне русло депонованих у тканинах або кістковому мозку клітин. Нейтрофіли це найбільша
лише 10 % від їхньої загальної кількості, а решта
носних
до місця зосередження інфекції лейкоцитів. Гепарин
Еозинофіли також здатні до фагоцитозу. Окрім цього, вони можуть чинити токсичну дію на клітини паразитичних тваринних організмів, зокрема гельмінтів, уможливлювати
реакції.
Іл. 116. Різноманітність лейкоцитів
(45–65 %)
(2–4 %)
(25–40 %)

в тканини. На відміну від нейтрофілів, фагоцитарна активність моноцитів найбільше спрямована проти вірусів. Лімфоцити беруть участь у здійсненні специфічного імунітету, про
без’ядерні формені
2–4•1011 в 1 л. Утворюються тромбоцити в червоному кістковому
руслі становить 10–12 діб,
які спричиняють звуження судин, злипання тромбоцитів


в разі механічного ушкодження судини
118). Унаслідок каскаду послідовного впливу одних чинників зсідання на інші утворюється речовина, яка має назву активатор протромбіну. Він, за умов наявності йонів Кальцію, перетворює протромбін на активну форму тромбін (іл. 118). Останній, у свою чергу, уможливлює перетворення глобулярного, розчиненого в плазмі, білка фібриногену на нерозчинний фібрин (іл. 118 ). Нитки фібрину зв’язуються зі стінками ушкоджених судин, клітинами крові, іншими фібриновими нитками, й утворюють згусток тромб. Після загоєння судини тромб розсмоктується внаслідок впливу білка плазміну.
Руйнування тромбоцитів і еритроцитів може відбуватися внаслідок їх зіткнень зі стінками судин. Оскільки всі чинники зсідання присутні в крові, то таке руйнування запускало б утворення мікротромбів. Проте в крові є речовини, які протидіють зсіданню крові. До таких речовин, зокрема, належать гепарин, гірудин (міститься
слині п’явок). Спадкову хворобу, за якої тромб формується
й людина може померти від крововтрат, називають гемофілією. Може формуватися і протилежний стан, за якого в організмі підвищується здатність до формування тромбів. Однією з причин може бути запалення стінки судини. Це може загрожувати спонтанною закупоркою кровоносних судин.
Іл. 118. Схема зсідання крові Руйнування ендотелію. Контакт зі сполучною тканиною
лікування вад серця, оригінальні
8 жовтня 1969
ходять у капіляри
рухається до дрібних вен, вони збираються
ково позбавлену кисню
час ознайомлення


яку називають верхівкою серця. Серце людини, як і всіх ссавців, містить чотири
два
і два шлуночки. Обидва передсердя, як і обидва шлуночки, відділені одне від одного перегородкою. На межі між передсердями та шлуночками
половинах серця є перегородка з клапанами. Отже, кров може надходити з передсердь до шлуночків, проте не може переходити між двома передсердями або двома шлуночками. Це необхідно для запобігання змішуванню артеріальної та венозної крові. Унаслідок такої будови крізь праву частину серця транспортується лише венозна
а
ліву лише артеріальна. У передсердя кров надходить венами, а від шлуночків кров рухається артеріями (іл. 120).
Стінка серця утворена трьома шарами. Зовнішній шар (епікард) утворений сполучною тканиною. М’язовою тканиною утворений серединний шар (міокард), який має найбільшу товщину. М’язова тканина серця має низку особливостей, які відрізняють її від посмугованих і непосмугованих м’язів. Міокард різних камер серця має неоднакову товщину: стінки передсердь тонші за стінки шлуночків, а стінка лівого шлуночка набагато товстіша за стінку правого. Внутрішній шар (ендокард)
вистеляє зсередини поверхню камер серця
три стулки, у лівій дві (іл. 121). До кожної стулки
прикріплена сухожилкова нитка, з’єднана із сосочковими м’язами (виростами міокарда). Під час підвищення тиску в шлуночку стулки клапанів сходяться, запобігаючи руху крові. Сухожилкові нитки не
стулкам вивернутися в порожнину передсердя. На межі між шлуночками й артеріями також є клапани, які називають
Цю властивість забезпечують
клітини міокарда,
потреб організму
нізмів регуляції (іл. 122). Нервова регуляція серцевої діяльності забезпечується симпатичними й парасимпатичними нервами, які іннервують центри автоматії. Симпатичні нерви посилюють серцеву діяльність, тобто збільшують частоту й силу скорочень. Парасимпатичні нерви (гілки блукального нерва), навпаки, послаблюють активність серця. Нервові центри, які впливають на роботу серця через симпатичні й парасимпатичні нерви, перебувають під контролем розташованих вище відділів нервової системи. Цим зумовлені зміни серцевої діяльності в результаті м’язової роботи, різноманітних емоційних станів тощо.
нації відіграє гіпоталамус (див. параграф 11). Одним із чинників, який впливає






становить
довжину екватора Землі. Під час вивчення
буйте знайти пояснення, чому організм витрачає стільки «будівельного матеріалу» для утворення капілярів.
Типи кровоносних судин. Ми вже знаємо, що артеріями
ється від
капілярами кров
із дрібних артерій до дрібних вен. Саме в капілярах відбувається обмін

123).
є наявність у їхніх стінках кишенькових клапанів, що внеможливлюють зворотний рух крові (іл. 123).
Капіляри мають стінки, які складаються лише з одного шару клітин ендотелію. Це найдрібніші судини, діаметр яких становить 4–10 мкм, що збігається з діаметром еритроцитів (6–9 мкм) (іл. 123).
Велике та мале кола кровообігу. Сукупність усіх судин утворюють
велике та мале кола кровообігу (іл. 124).
Велике коло починається від лівого шлуночка. Артеріальна кров з нього виштовхується в аорту найбільшу артерію організму. Від самого початку аорти відгалужуються невеликі судини, які постачають кров’ю серцевий м’яз, вінцеві, або коронарні
дугу аорти (у людини, як і в усіх
якої відходять великі артерії, що галузяться. У тканинах різних органів великі артерії розпадаються на низку більш дрібних, які переходять в артеріоли й капіляри. У капілярах великого кола
кров’ю і тканинною рідиною відбувається обмін речовинами. Із крові до тканин надходять кисень, глюкоза та інші поживні речовини. Із тканин
вуглекислий газ та інші продукти
перетворюється на венозну.
Іл. 124. Велике та

чотирьох легеневих венах (по дві від кожної легені),
стінок аорти відповідно серцевим скороченням називають пульсом, який можна виміряти (іл. 125).
Характеристика кровотоку. Кровоток має низку показників, деякі з яких ми опишемо. Рушійною силою, яка спричинює рух крові та зумовлює його напрямок, є кров’яний тиск.
Іл. 125. Вимірювання пульсу Пульс це показник, який свідчить про ритмічність серцевих скорочень та їхню силу. У місцях, де артерії розміщені близько до шкіри, такі коливання можна відчути пальцями як легенькі поштовхи. Число пульсових поштовхів за хвилину відповідає частоті серцевих скорочень. Нормальні значення цього показника становлять від 60 до 90 ударів на хвилину. Одним із методів є вимірювання пульсу на променевій артерії. Вона залягає

напрямку через наявність у венах кишенькових клапанів. Ще однією рушійною силою току крові є присмоктувальна дія серця під час розслаблення й наповнення кров’ю передсердь. Лінійна швидкість руху крові це швидкість, з якою рухається окрема часточка крові (наприклад, один еритроцит). Цей показник прямо залежить від кров’яного тиску в судинах й обернено від їхнього діаметра (іл. 126). Отже, підвищення кров’яного тиску на початку судини супроводжується прискоренням лінійної швидкості крові, а зниження тиску її зменшенням. У разі звуження судини швидкість руху крові в ній збільшується, і навпаки. Порівнявши діаметри артерій, вен і
лярів, можна зробити хибний висновок, що найвищою
буде в капілярах. Насправді, для встановлення такої закономірності необхідно враховувати площу
(4 см2) є меншою, ніж сума площ перерізів
перерізу
Тиск
Аорта 80–120 мм рт. ст.

Капіляри близько 20 мм рт. ст. (велике коло кровообігу)
нижня порожниста вена
0 мм рт. ст.
Лінійна швидкість
Аорта 0,45–0,5 м/с
Капіляри 0,5–1,0 мм/с
(0,05–0,10 см/c)
Вени 0,1–0,25 м/с.
Проаналізуйте наведені
§ 28. Хвороби серцево-судинної системи.
За статистикою, хвороби серцевосудинної системи посідають перше місце поміж захворювань, які спричиняють смерть людини. На розвиток цих захворювань впливає велика кількість чинників, зокрема генетичні особливості людини, незбалансоване харчування, вплив стресових ситуацій, шкідливі звички — тютюнопаління та зловживання алкогольними напоями. Хвороби серцево-судинної системи. Ішемічна хвороба серця пов’язана з недостатнім кровопостачанням серцевого м’яза кров’ю, що знижує надходження до нього кисню й поживних речовин. Причиною цього може бути звуження стінок коронарних судин унаслідок
відмирання тканин, що постачаються ними

скорочення. Основні форми аритмій такі: тахікардія суттєве підвищення частоти серцевих скорочень (100 уд./хв чи більше); брадикардія уповільнення серцевого ритму (нижче 60 уд./хв). Зважаючи на перераховані причини хворіб серцево-судинної системи, можна виокремити чинники попередження цих захворювань, які наведені на рисунку (іл. 127).
Кровотечі. У процесі руйнування стінок кровоносних судин можуть виникати кровотечі. Розрізняють зовнішні та внутрішні кровотечі. У разі зовнішніх кров виливається на поверхню організму, у разі внутрішніх у порожнини організму
тканини. Це загрожує втратою організмом крові, що може призвести до порушення функціонування всіх його тканин. Кровотечі
швидко припиняються завдяки процесам
крові. Натомість ураження великих судин (артерії, вени) є більш небезпечним. Найбільшу загрозу для життя становлять артеріальні кровотечі. Через високий тиск крові в них ускладнюється утворення тромбів та відбувається інтенсивна
втрата крові. Для надання невідкладної допомоги можна використовувати різні методи зупинки кровотечі (іл.
надання
людини.
Іл 128. Методи зупинки кровотечі: а натискання; б використання тампона; в використання джгута
Перев’яжіть поранення чистими бинтами або підручною тканиною: рушником, футболкою тощо
Тримайте рану під тиском щонайменше 3 хвилини після
Накладіть на 5–7 см вище рани Зафіксуйте час накладання джгута Не знімайте
Лімфа — давньоримська богиня
з дванадцяти сільськогосподарських
пов’язано з тим, що в
називають лімфатичною системою?
Лімфатична система. Складниками цієї системи є лімфатичні капіляри (найдрібніші судини), лімфатичні судини, лімфатичні вузли й лімфатичні протоки, які забезпечують рух лімфи (іл. 129). Лімфа прозора, жовтуватого кольору рідина, яка за своїм складом подібна до плазми крові й містить лімфоцити. Частина лімфоцитів потрапляє в лімфатичні капіляри з тканинної рідини, а частина утворюється у лімфатичних вузлах.
Лімфатичні капіляри закінчуються сліпо, а їхня стінка складається
одного шару епітеліальних клітин із
тканинах
унаслідок чого утворюється лімфа.
носних капілярах, у лімфатичні капіляри можуть проходити сполуки, молекули яких
зливаються та утворюють лімфатичну судину, у стінці

впадає в праву підключичну вену (іл. 129).
Функції лімфатичної системи. Лімфатична система виконує дренажну, захисну, транспортну й кровотворну функції. Дренажна функція полягає в тому, що по лімфатичних каналах відтікає надлишок міжклітинної (тканинної) рідини. Цей надлишок утворюється через різницю в об’ємах рідини, яка вийшла з кровоносних капілярів і повернулася до них, а також унаслідок утворення метаболічної води під час окиснення органічних речовин. Об’єм лімфообігу становить 2–4 л
на добу, проте, якби ця рідина залишалася в тканинах, це призвело б до їх набряку, що мало би негативні наслідки (іл. 130). Транспортна функція зумовлена тим, що з лімфою переносяться речовини, які важко або зовсім не проникають крізь стінки кровоносних капілярів. Пригадайте особливості всмоктування речовин до лімфатичних капілярів у ворсинках тонкої
речовин належать, зокрема, продукти розщеплення ліпідів. Окрім них, лімфа може транспортувати й деякі великі білки. Лімфатичні вузли містять велику кількість фагоцитів і лімфоцитів, чим
параграф 30). Кровотворна
тичних
Іл. 130. Дренажна функція лімфатичної

забезпечує імунітет. Імунітет сукупність реакцій, скерованих на підтримку генетичної сталості організму й боротьбу зі збудниками захворювань.
Класифікації типів імунітету. За механізмом реалізації розрізняють клітинний і гуморальний імунітет. Перший здійснюється спеціалізованими імунними клітинами, другий за допомогою різних
притаманна протимікробна
бактерій. Хлоридна
комплексу білків немає або він має відмінну будову, клітина ідентифікується як чужорідна і знищується. Так можуть знищуватися чужорідні клітини (наприклад, бактерії) та клітини власного організму, інфіковані вірусами або ж генетично змінені. Цей тип імунітету забезпечується переважно окремим типом лейкоцитів крові NK-клітинами (NK від англ. natural killers, «природні вбивці»), а також може здійснюватися макрофагами клітинами тканин, здатними до фагоцитозу.
Специфічний гуморальний імунітет пов’язаний із виділенням спеціалізованих захисних білків антитіл (імуноглобулінів). Вони продукуються одним з типів клітин
B-лімфоцитами. Антитіла здатні високоспецифічно
чужорідними білками, які виробляються інфекційними агентами. Висока специфічність означає, що антитіло ефективно
«своїм» антигеном (іл. 132). Під час
починає інтенсивно ділитися. Утворені внаслідок
клітини продукують антитіла, які знешкоджують антигени.
в різний спосіб: шляхом своєрідного
(іл. 133). Специфічний
розпізнавати чужорідні
останніх. Саме Т-хелпери уражаються вірусом імунодефіциту
стадіях
кількості антитіл. Природний пасивний імунітет захищає новонароджену дитину. Одразу після народження її власна імунна
забезпечувати захист повною мірою,
від материнського
імунітет формується шляхом вакцинації. Штучний пасивний імунітет пов’язаний із введенням в організм готових антитіл проти
збудника імунної сироватки. Її використовують, якщо необхідно швидко побороти наявний у крові збудник
вилікувати дуже ослаблений організм. Імунний захист при цьому триває недовго. Поняття алергії. Особливою формою
відповіді є
Вона виявляється як підвищена реактивність на певні антигени (пилок квітів, шерсть тварин тощо) алергени (іл. 134). Зовнішніми виявами алергії є набряки слизових оболонок, розвиток запальних процесів (набряк, почервоніння, свербіння), підвищена чутливість верхніх дихальних шляхів (кашель, чхання, нежить). Більшість цих симптомів викликана виділенням у тканинах речовини гістаміну. Отже, алергія це реакція гіперчутливості імунної системи, запуск захисних реакцій на
стимули, що не є шкідливими для організму.
Іл 134. Найпоширеніші
українських дослідників і дослідниць (іл. 135). Збудниками власне інфекційних хвороб є прокаріоти й віруси. Також виділяють інвазійні, або паразитарні хвороби, викликані евкаріотичними організмами: одноклітинними гетеротрофними евкаріотами, гельмінтами, комахами тощо. Шляхи зараження інфекційними агентами. Можна вжити ефективних профілактичних заходів, якщо знаєш шляхи зараження інфекційними агентами. Часто це нескладні правила поведінки, дотримання яких кожна людина може контролювати самостійно. Хвороби органів дихальної системи часто поширюються повітряно-крапельним шляхом (іл. 136, 1). Людина, яка хворіє, може чхати, кашляти, унаслідок чого поширює навколо себе мікрокраплини слизу, що містять інфекційний агент. Люди, які перебувають поруч, можуть вдихнути їх і заразитися. Способом поширення кишкових інфекцій та інвазій є фекально-оральний (іл. 136, 2). Збудник виходить із

та інвазійних хвороб ви ознайомилися під час вивчення курсу біології в 7 класі, що допоможе вам сформулювати заходи щодо профілактики таких хвороб. Трансмісивні хвороби поширюються за допомогою тварин-переносників. Наприклад, це можуть бути комарі (малярія), мухи (сонна хвороба), кліщі (кліщовий енцефаліт, хвороба Лайма), блохи (чума), воші (тиф) тощо (іл. 136, 3). Часто збудник хвороб людини може мешкати в популяціях диких тварин, які є природним резервуаром. Для профілактики таких хвороб необхідно контролювати популяції таких тварин. Деякі збудники, наприклад віруси
типу В та С, ВІЛ, можуть передаватися шляхом контакту
або тварини. У цьому випадку чинниками
контроль за якістю крові донорів
є
час переливання, використання погано стерилізованого медичного або косметологічного обладнання, повторне використання шприців тощо (іл. 136, 4). Хвороби, які поширюються через кров, можуть передаватися від матері до дитини під час вагітності (іл. 136, 5).
Велику групу становлять захворювання, що передаються статевим шляхом (ЗПСШ) (іл. 136, 6). Їх збудниками можуть бути віруси (ВІЛінфекція, герпес, гепатит В, папілома), бактерії (гонорея, сифіліс, Іл. 136. Основні

лікування або зменшення негативних наслідків, адже існує можливість пройти анонімне лабораторне
Поняття імунотерапії. Для ефективної
хворобами імунітетові інколи
Імунотерапія це спосіб лікування захворювань шляхом активації або пригнічення функціонування імунних механізмів
сироваток. Сироватки
товляють із крові імунізованих
Широко застосовують сироватки проти токсинів небез-
отрути змій, збудників хвороб (грипу, сибірки,

покращила ситуацію з іншими небезпечними інфекціями: гепатитом В, туберкульозом, дифтерією, правцем, кашлюком, поліомієлітом, коровою інфекцією тощо. До винайдення вакцинації ці хвороби були поширеними причинами дитячої смертності або інвалідизації. Щеплення проти них роблять у дитячому віці з повтором у підлітковому та дорослому відповідно до календаря вакцинації. На жаль, у сучасному суспільстві трапляються «антивакцинаторські» настрої, їх прихильники приписують вакцинації спричинення різних патологій. Такі уявлення не мають наукового підґрунтя і є небезпечними для громадського здоров’я. Варто пам’ятати, що імунізація
дорослим людям не можна робити щеплення
протипоказаннями, деякі види щеплень мають
вакцинації не є стовідсотковою. Якщо переважна частина населення є імунізованою, поява хворої
епідемії, бо її будуть оточувати несприятливі до збудника
імунітет: імунізовані люди захищають неімунізованих (іл. 138). Зменшення кількості вакцинованих
руйнує колективний імунітет. Із цим пов’язано, зокрема, ускладнення в Україні
люди, які хворіють
1. Ніхто не імунізований, хвороба швидко
2.
3.
перебіг процесів в організмі, що залежать
утворення ферментів,
перебіг процесів в організмі, що залежать від енергії АТФ, наприклад утворення ферментів, медіаторів тощо.» Завдання 1. Проаналізуйте твердження. Чи є поміж них такі, що можна сформулювати на основі аналізування наведеної інформації?
сформулювати на основі аналізування наведеної інформації?
І. Нестача кисню під час підйому людини в гори зумовлює зниження кількості енергії, яка утворюється
І. Нестача кисню під час підйому
кількості енергії, яка утворюється
ІІ. Унаслідок зниження
ІІ. Унаслідок зниження
Б лише ІІ твердження
твердження
В обидва твердження
В обидва твердження
Г немає таких тверджень
таких
Завдання
гемоглобіну киснем і залежності
гемоглобіну киснем і залежності атмосферного тиску
рівнем моря. Учень за-
рівнем моря. Учень за
значив, що зі збільшен-
значив, що зі збільшен
ням висоти над рівнем
ням висоти над рівнем
моря насичення гемо
глобіну киснем знижу
ється. Учениця висло
моря насичення гемоглобіну киснем знижується. Учениця висло-
вила судження, що це
вила судження, що це
пов’язано зі зростанням атмосферного тиску.
пов’язано зі зростанням
тиску.
А лише учень Б лише
А лише учень

Самоконтроль
1. Еритроцит


2. Що з
А еритроцит Б тромбоцит
В інтерферон Г фібриноген
3. Тромбоцити
А транспортування
Б захист
В транспортування амінокислот
Г зсідання крові
поранення
4. Одним із чинників зсідання крові є
А лізоцим
Б альбумін
В інтерферон
Г фібриноген
5. Велике коло кровообігу починається током крові з
А правого шлуночка
Б лівого шлуночка
В лівого передсердя
Г правого передсердя
6. Одним із заходів попередження серцево-судинних хвороб є А дотримання режиму праці й відпочинку
Б контролювання кількості комах-переносників В дотримання правил гігієни під час уживання їжі Г використання стерильних

8. Особливістю вен людини є
9. Прочитайте текст: «Специфічний гуморальний імунітет
з виділенням захисних білків — (1), які продукуються (2)». Правильний варіант для заповнення пропусків (1–2) наведено в рядку
А 1 інтерферонів, 2 Т-лімфоцитами
Б 1 інтерферонів, 2 В-лімфоцитами
В 1 імуноглобулінів, 2 В-лімфоцитами Г 1 імуноглобулінів, 2 Т-лімфоцитами
Тестові завдання з однією відповіддю (1,5 бала)
10. Ознайомтеся з описом зображеної на рисунку частини кровоносної системи: «Цифрою 1 на рисунку позначено артерію, якою транспортується

рисунку механізм взаємодії антитіла з антигеном,
зв’язування позначене буквою Х. Учень зазначив, що антитіло зв’язується лише зі «своїм» антигеном. Учениця зауважила, що антитіло — це захисний білок імуноглобулін. Чи має хтось із них рацію?
А лише учень
Б лише учениця
В обоє мають рацію
Г обоє помиляються
Тестове завдання з однією відповіддю
1 150–400 тис. 2 4–5,5 млн 3 6–10 тис.
1 має

повітроносні шляхи, які поділяють на верхні й нижні, та легені (іл. 139). До верхніх дихальних шляхів
У них повітря зігрівається, частково зволожується, очищається від пилу й інших дрібних часточок. Поверхня дихальних шляхів утворена одношаровим війчастим (миготливим) епітелієм. Між війчастими клітинами розташовані залозисті клітини, які виділяють слиз. Дрібні часточки, що містяться в повітрі, затримуються в слизі,
нюховий епітелій


люється
Завдяки скороченню голосових м’язів змінюється розмір голосової щілини. Якщо це відбувається ритмічно, то
потік повітря, яке проходить крізь цю щілину, також набуває ритміки. У такий спосіб формуються звукові коливання. Отже, описаний складник гортані є голосовим апаратом, що слугує для утворення звуків. Трахея
порожня трубка, яка не спадається завдяки наявності в її стінках хрящових напівкілець. Трахея поділяється на два бронхи, що прямують до правої та лівої легені. Бронхи діляться і утворюють дрібні бронхіоли, з яких повітря надходить до легеневих альвеол. Легені займають більшу частину
порожнини. Зовнішня поверхня легень утворена сполучнотканинними листками плеврою. Зовнішній плевральний листок із середини приростає до грудної клітки та діафрагми. Внутрішній плевральний листок зрослий із тканиною легень. Між цими двома листками є плевральна порожнина, заповнена рідиною і герметично замкнена. Альвеоли легень утворені одним шаром епітеліальних клітин (іл. 141). Вони є гронами заповнених повітрям
кульок. Внутрішня поверхня альвеол укрита шаром речовин (сурфактант), функцією яких є зменшення поверхневого натягу альвеолярних стінок, що запобігає їх спаданню. Зовні альвеоли обплетені легеневими
капілярами.
Іл. 140. Будова
а у відкритому стані;
б у закритому стані



ребрами є дві групи м’язів зовнішні та внутрішні
одне до одного знизу вгору.
грудною і черевною порожниною.
у грудну порожнину. Під час
вдиху (іл. 142, а).
Іл. 142. Механізм


(іл. 142,
Виділяють черевний і грудний типи дихання. У першому випадку дихання здійснюється за участі переважно м’язів живота й діафрагми. У другому
випадку основна роль належить м’язам грудної клітки. У жінок переважає грудний тип дихання, а в чоловіків черевний.
Показники зовнішнього дихання. Частота дихання в стані
спокою становить 12–16 вдихів за хвилину. Виділяють такі показники зовнішнього дихання: дихальний об’єм кількість повітря, яку людина вдихає або видихає за один раз у стані спокою (близько 500 мл); резервний об’єм вдиху кількість повітря, яку людина може максимально вдихнути після нормального вдиху (1,5–2,5 л); резервний об’єм видиху кількість повітря, яку людина може максимально видихнути після нормального видиху (1–1,5 л); життєва ємність легень максимальна кількість повітря, яку людина може видихнути після максимального вдиху, є сумою дихального й резервних об’ємів вдиху та видиху (4–5 л). Навіть після максимального видиху в легенях і повітроносних шляхах залишається певна кількість повітря залишковий об’єм легень, який становить 1–1,5 л. Під час кожного вдиху змішуються атмосферне повітря
суміш альвеолярних газів (іл. 143).
Іл. 143. Основні показники зовнішнього
альних тисках (напрузі) дихальних газів. Унаслідок цього відбувається дифузія кисню в капіляр, а вуглекислого газу до альвеоли (іл. 144). Отже, кисень, що надійшов у кров, транспортується в еритроцитах до тканин, де від’єднується та спрямовується до клітин. Вуглекислий газ транспортується в протилежному напрямку. Варто зазначити, що об’ємна частка як кисню, так і вуглекислого газу в крові є більшою за таку в альвеолярній суміші. Це є наслідком ефективного зв’язування
обох речовин в еритроцитах. Регуляція дихання. Як і кровообіг, дихання регулюється нервовими й гуморальними шляхами. Головна
дихальному центру довгастого мозку. У ньому функціонально
три групи нейронів: «центр вдиху», «центр видиху», а також нейрони, що забезпечують плавну зміну вдиху


дихальних шляхів.
центру й спричинює гальмування центру
центру видиху. У такий спосіб відбувається
ному розтяганню легень (іл. 145). Окрім описаних головних чинників, які впливають на дихання, певна роль належить терморецепторам (затримка дихання під час різкого охолодження) і механорецепторам шкіри (лоскотання). Із хеморецепторів і механорецепторів верхніх дихальних шляхів починається ряд захисних рефлексів кашель, чхання, затримки дихання, а також орієнтувальний рефлекс принюхування. Робота дихального центру, своєю чергою, перебуває під контролем розташованих вище відділів нервової системи. Так, на дихання може впливати гіпоталамус, а також кора великих півкуль. Вплив останньої є необхідним для забезпечення нашої здатності до мовлення (іл. 145). Характер дихання формується внаслідок взаємодії всіх чинників. Так, ми можемо свідомо затримати дихання, проте лише до певного ступеня. Щойно концентрація вуглекислого газу стане занадто високою, вдих відбудеться незалежно від нашого бажання.
Іл. 145. Регуляція дихання







Розтягання легень Скелетні м’язи
Видатному українському лікарю, ученому в
медицини та біокібернетики Миколі Амосову належить
знати, що переїдання, фізична детренованість, психічне перенапруження й відсутність
їхніх хвороб». Значення цих стимулів ми розглянемо в параграфі. У попередньому параграфі ми розглянули, як відбувається регуляція дихання. Ці
розкрити рот або у випадку
дихального центру людина може почати дихати самостійно.
ється набряком, фільтрацією
рідини, втратою нюхової чутливості тощо. Він може виникати як самостійне захворювання або як компонент інших респіраторних захворювань. Ангіна гострий запальний процес, що спричиняють бактерії. Під час неї уражається слизова оболонка горла та глотки, спостерігається виражене запалення глоткових лімфатичних вузлів («мигдалин»). Симптомами ангіни є висока температура, біль у горлі, особливо під час ковтання. Бронхіт запалення бронхів. Це захворювання можуть викликати віруси, бактерії, хімічні речовини, що подразнюють слизову оболонку дихальних шляхів, фізичні чинники, зокрема переохолодження. Ознакою бронхіту є кашель рефлекторна реакція, яка виникає в результаті подразнення рецепторів стінок
Бронхіальна астма — це захворювання дихальних шляхів, яке характеризується запальним процесом і спазмом бронхів (іл. 147). Воно може виникати в будь-якому віці, але найчастіше розвивається в дитинстві. Це захворювання може бути спадковим, а може бути набутим, як результат впливу чинників навколишнього середовища, зокрема забруднення повітря, алергії. Симптомами бронхіальної астми є задишка, для якої характерним є утруднений видих, особливо вночі або після фізичного навантаження; часті напади нічного кашлю або ранковий кашель Іл. 147. Бронхи людини: а — у нормальному стані;

ційне захворювання з хронічним
зокрема туберкульозна паличка (іл. 148). Грип вірусне захворювання з можливістю тяжких ускладнень і ризиком смерті. Для хвороби характерна виражена інтоксикація організму із суттєвим підвищенням температури тіла. Епідемії вірусів, які охоплюють цілі континенти, називають пандеміями. Наприклад, унаслідок пандемії грипу 1918 року загинули від 50 до 100 мільйонів людей, а пандемія викликаної SARS-CoV-2 хвороби Covid-19
2 роки призвела

біль у грудній клітці підвищена



шляхів і вчасне їх лікування є профілактикою розвитку бронхіальної астми. Важливу роль відіграє гігієна приміщення, у якому перебуває людина. Оптимального стану повітря в приміщенні досягають провітрюванням, обігрівом холодного повітря, зволоженням у випадку надлишкової його сухості. Сприятливо впливають на вентиляцію легень фізичні вправи. Украй необхідно додержуватись раціонального харчування. Раціон має містити достатню кількість білків і вітамінів, зокрема вітаміну А, С тощо. До шкідливих звичок можна віднести вживання алкоголю і тютюнопаління. Негативний вплив обох звичок на
відомий це збільшення ймовірності розвитку серцево-судинних патологій, ракових захворювань тощо (іл. 149). Уживання алкогольних напоїв є причиною понад 5 % смертей щороку. Захисні сили організму хворих на алкоголізм або курців знижуються, що призводить до збільшення ймовірності розвитку інфекційних захворювань, насамперед респіраторних. Переважна частина
рівнем економічного розвитку. На жаль, статистика в Україні також невтішна: курить кожна четверта людина, а близько 80 % дорослих курців починають курити у віці до 18 років. Відмова

Герман
Уривок (англійська мова)
But owing to his marked internal structure which gives him regular lungs, like a human being’s, the whale can only live by inhaling the disengaged air in the open atmosphere. Wherefore the necessity for his periodical visits to the upper world.
Уривок (німецька мова)

Der Wal dagegen verfügt aufgrund seiner besonderen Anatomie über richtige Lungen, genau wie der Mensch, und kann deshalb nur leben, indem er die ungebundene Luft aus der freien Atmosphäre einatmet. Daher also die unerläßlichen regelmäßigen Ausflüge an die Oberwelt.
Уривок (французька мова)
Mais la constitution interne de la baleine, comportant de véritables poumons, pareils à ceux de l’homme, ne lui permet pas de vivre sans respirer l’air libre. C’est pourquoi lui sont nécessaires ses visites périodiques au monde supérieur.
Уривок (іспанська мова)
Pero, debido a su diversa estructura interna, que le da unos pulmones normales, como los de un ser humano, la ballena solo puede vivir inhalando el aire desprendido que hay en la atmósfera abierta. De ahí la necesidad de sus visitas periódicas al mundo de arriba.
Самоконтроль рівня
Тестові завдання з однією відповіддю (0,5 бала)

1. Оберіть правильний перелік органів дихальної системи. А ротова порожнина, гортань В носова порожнина, глотка Б носова порожнина, трахея Г ротова порожнина, легені
2. Голосові зв’язки розташовані в
А трахеї В легенях Б гортані Г бронхах
3. Газообмін відбувається в
А трахеї Б гортані В бронхах Г легенях
4. У носовій порожнині відбувається
А знезараження вдихуваного повітря Б зволоження видихуваного повітря В газообмін між кров’ю та повітрям Г зігрівання видихуваного повітря
5. Дихальний об’єм легень становить близько А 500 мл В 1,5–2,5 л Б 1–1,5 л Г 4–5 л
6. Оберіть причину захворювання людини на
А Дія на організм забрудненого повітря Б Вплив на організм певного вірусу В Може успадковуватися від батьків
Г Тривалий вплив тютюнового диму
Тестові завдання з однією відповіддю (1 бал)
7. Проаналізуйте твердження щодо зображених
дихальної системи.
І. Цифрою 1 позначено трахею.
ІІ. Цифрою 2 позначено легені.
рисунку

9. Проаналізуйте схему газообміну в легенях. Буквами (А–Г) позначено складники, які задіяні в цьому процесі.
Який підпис зроблено ПОМИЛКОВО?
А еритроцит
Б тромбоцит
В альвеола Г капіляр
Тестові завдання з однією

(1,5 бала)
10. Прочитайте опис: «Складник дихальної системи, який забезпечує
газообмін, — це (1). Газообмін відбувається унаслідок (2) газів». Правильний варіант для заповнення пропусків (1, 2) наведено в рядку
А 1 альвеола, 2 випарування
Б 1 бронх, 2 фільтрації
В 1 альвеола, 2 дифузії
Г 1 трахея, 2 дифузії
11. На уроці біології дві учениці обговорювали регуляцію
учениця зауважила, що головна роль у
хальному центру
буквами А–В. Оберіть правильні твердження.




токсичних сполук, які потрапили
лення забезпечують різні органи (іл. 150). Процеси газообміну, що
ваються в легенях, уможливлюють видалення
газу, води у вигляді пари та
печінки зумовлена утворенням
дяться, зокрема, кінцеві продукти розщеплення
метаболізму, що надходять із жовчю.
також виділяються
сечовина), про що ви
сечоводи, сечовий






на піраміди (від 8 до 16). Піраміди направлені своїми гострими кінцями до центральної порожнини нирок миски (іл. 151). Від миски починається сечовід. Кожен сечовід впадає в сечовий міхур порожнистий орган, основною функцією якого є збирання, накопичення й виведення сечі з організму. Його стінка утворена трьома шарами: зсередини він вкритий багатошаровим незроговілим епітелієм, середній шар утворений гладенькою м’язовою тканиною, а зовнішній сполучною тканиною. Від сечового міхура відходить сечовипускний канал, яким сеча виводиться з організму людини (іл. 151).
Нефрон як складник нирки. Нефрон складний багатоклітинний утвір. Він складений з ниркового тільця й системи канальців (іл. 152).
Складниками ниркового тільця є клубочок, утворений дрібними кровоносними судинами, і капсула клубочка. Капсула клубочка має форму чаші з подвійними стінками. Кожна стінка утворена одношаровим епітелієм. Капсула огортає клубочок (іл. 152). До клубочка крізь приносну артеріолу надходить кров. Пройшовши крізь систему капілярів, кров відтікає по виносній артеріолі. Надалі виносна артеріола прямує до системи ниркових канальців, де знову розгалужується на капіляри. Від
них кров відтікає крізь венули, які
Іл. 151. Сечовидільна система:


Цей процес відбувається в нирковому тільці. Фільтрація
приносна артеріола має більший
дить
лярів, у якому є численні
Іл. 152. Будова нефрона

суттєве зниження об’єму сечі. Також у звивистих канальцях відбувається секреція транспортування речовин із клітин стінок канальців до їхнього просвіту. У такий спосіб до сечі надходять йони K+, Na+, H+, Cl¯, деякі органічні кислоти, амоніак, компоненти лікарських засобів тощо. Ці процеси завершуються в збірних трубочках, і рідину, яка протікає в них, називають вторинною, або кінцевою, сечею. Склад плазми, первинної та вторинної сечі ви можете проаналізувати з даних таблиці (іл. 153). Унаслідок процесів реабсорбції вторинна сеча суттєво відрізняється за хімічним складом від плазми
істотно підвищується
ратури повітря
свідомо керувати процесом сечовиділення (іл. 154). Основними гуморальними чинниками,

спричиняють запальні процеси. Вони потрапляють крізь кров від інших внутрішніх органів або крізь сечівник. Запалення мискової та коркової частини нирок має
частини нирок із нефронами
оболонки сечового міхура цистит, а сечовипускного каналу уретрит. Порушення процесів фільтрації в нирках неминуче призводить до отруєння організму. Ураження нирок може супроводжуватися як збільшенням, так і зменшенням сечовиділення. Це призводить до розладів функціонування серцево-судинної системи, з-поміж яких найчастіше трапляється хронічне підвищення артеріального тиску (гіпертонія). Розвитку хвороб сприяють переохолодження організму, інфекційні захворювання інших систем організму, недотримання правил особистої гігієни. Шкідливий вплив має незбалансоване харчування, уживання страв із додаванням великої кількості солі, унаслідок чого в організмі затримується вода. Уживання алкоголю та тютюнопаління супроводжується інтоксикацією нирок, що призводить до зниження їхньої функції. Алкогольні напої уражають клітини епітелію нирок, унаслідок чого зростає ризик ускладнення захворювань. Розуміння причин хвороб допоможе свідомо дотримуватися правил їх профілактики (іл. 155).
Іл. 155. Правила профілактики
Раціональне харчування
Дотримання правил особистої гігієни Помірні фізичні навантаження, дотримання режиму дня
сечовидільної системи
Уникнення шкідливих звичок
Уникнення переохолодження, вчасне лікування карієсу, ангіни
Регулярне спорожнення сечового міхура й кишечника


та функції шкіри. Шкіра це зовнішні покриви тіла людини,
організмів. Для розуміння
на шляху хвороботворних
рений багатошаровим
поділу, а верхні шари відмирають і формують зроговілий
Меланін виконує
Під епідермісом розміщена власне шкіра, або
шари
Іл. 156. Будова шкіри































































































































шкірі міцності та пружності. У дермі є кровоносні та лімфатичні судини, які забезпечують живлення клітин як дерми, так і епідермісу. У сітчастому шарі розташовані потові й сальні залози, волосяні сумки. Протоки потових залоз відкриваються на поверхні шкіри. Піт містить воду, неорганічні йони та деякі продукти метаболізму. Випаровування води з потом забезпечує терморегуляторну функцію шкіри, про яку більш детально ви дізнаєтесь із наступного параграфа. Виділення з потом надлишку води й продуктів обміну речовин
функцію. Зокрема,
мл води. Запах поту визначається індивідуальними особливостями обмінних процесів. Неприємний
внаслідок розщеплення органічних речовин поту бактеріями, які живуть на поверхні шкіри. Потовиділення суттєво підвищується під час фізичної роботи. Сальні залози відкриваються у волосяні сумки й забезпечують змащування волосся і шкіри жирним секретом, що запобігає їх пересиханню. Особливим типом шкірних залоз є
залози. Вони закладаються в представників обох
вають у зачатковому
жирової


життя. Жировий прошарок помірної
виконує функції
нічного захисту, збереження теплоти (термоізоляції) та депонування поживних речовин. Зокрема, тут відкладається жир, а також вона бере участь у синтезі вітаміну D. Похідні шкіри. Похідними шкіри є волосся, яке трапляється
її поверхні, за винятком
тощо. Основною речовиною волосся та інших похідних шкіри є білок кератин. Волосина складається зі стрижня й кореня. Стрижень виступає зі шкіри, а корінь розмі-
сумки, де містяться епітеліальні клітини, здатні
меланіну. Із віком
фолікулах, а отже й знижується синтез

а положення брів є одним із важливих виявів емоцій. Іншими похідними шкіри є нігті, які розвиваються з клітин епідермісу. Можна вивчити їхню будову під час виконання лабораторного дослідження, порівнявши зображення нігтя (іл. 159) з нігтями на руках. Нігті — це тонкі, опуклі зроговілі пластинки на кінцях фаланг пальців рук і ніг. Ніготь складається з нігтьової пластинки, яка розташована на нігтьовому ложі. Видима частина нігтьової пластинки утворена переважно відмерлими клітинами. Нижня частина нігтьової пластинки (лунула) у формі білуватого півмісяця є видимою частиною кореня нігтя. Він складається з клітин, які активно розмножуються і забезпечують ріст нігтьової пластинки. До нігтьового ложа підходять капіляри, які забезпечують надходження поживних речовин. Задній і бічні краї

теплоутворення й тепловіддавання. Терморегуляція. Людина належить
нізмів, температура тіла

випадку говорять про тепловий або сонячний удар. Тепловий удар стан, пов’язаний із розладом терморегуляції та перегріванням організму загалом. Сонячний удар виникає у випадку місцевого перегрівання голови під впливом прямого сонячного випромінювання.
Ознаками перегрівання є головний біль, слабкість, інтенсивне виді-
лення поту, слабкий частий пульс, можливі нудота, блювання, спрага, бліда й холодна шкіра. У разі погіршення стану можна говорити про тепловий або сонячний удар, який характеризується підвищенням температури тіла понад 39,5–40 °С, прискореним серцебиттям, пульсом 100–130 і вище ударів на хвилину. У людини можливе запаморочення чи непритомність, м’язові судоми, червона суха або волога шкіра. Цей стан потребує надання допомоги, етапи якої наведено на ілюстрації 161. Тепловий і сонячний удари можна попередити. Для цього влітку ми маємо вдягати світлий легкий
тканин (льон, бавовна),
можливості часто провітрювати





шкіри. Стани ураження шкіри, за яких можливі висипи, свербіж, почервоніння, запалення можуть свідчити про її захворювання. Поміж хвороб вирізняють інфекційні, які виникають унаслідок впливу бактерій (наприклад фолікуліт), вірусів (герпес, вітряна віспа тощо). Порушення правил особистої
може
ризики паразитарних захворювань шкіри, які спричинюють деякі
грибів, червів, членистоногих (іл. 162). Хвороби можуть бути
порушення обміну речовин, розладів функціонування ендокринної, нервової або імунної системи. Можна навести приклад псоріазу автоімунного захворювання. Псоріаз спричинюється порушенням імунної відповіді, яка зумовлює надмірне утворення клітин шкіри й викликає хронічне запалення її ділянок. Чинником виникнення
також неконтрольоване
захворювань шкіри.


симпатичної нервової системи та підвищення рівня кортизолу, що знижує імунний захист. Варто нагадати, що раціональне харчування, дотримання режиму дня, загартовування є важливими чинниками збереження здоров’я. Своєю чергою, стан шкіри може слугувати індикатором порушення здоров’я. Тому, якщо на обличчі є висип, треба йти до лікаря. Перша допомога при термічному ураженні шкіри. Пошкодження шкіри, спричинені впливом гарячого предмета, рідини високої температури або вогню, називають термічним опіком. Термічні опіки часто супроводжуються такими симптомами, як почервоніння або лущення шкіри, виникненням пухирів і набряку, появою блідості
обвуглення шкіри. Важливо швидко надати людині адекватну першу допомогу. Насамперед необхідно негайно промити уражену ділянку шкіри водою кімнатної температури, що допоможе знизити її температуру. Одяг, що розташований поблизу ділянки опіку, необхідно зняти, проте не можна чіпати речей, які прилипають до ураженої шкіри. Надалі прикрити рану стерильною пов’язкою (іл. 163). Дати потерпілому або потерпілій випити води, щоб



Завдання
пошуках медичного закладу, що спеціалізується на діагностуванні та лікуванні сечовидільної системи.




Завдання 2. Проаналізувавши подану на сайті інформаційну
Самоконтроль рівня
Тестові завдання з однією відповіддю (0,5 бала)
1. Структурною одиницею будови нирки є
А нейрон В капіляр Б нефрон Г альвеола
2. У нирці фільтрація відбувається в
А сечоводах В клубочках нефронів Б нирковій мисці Г звивистих канальцях нефронів
3. Запалення сечового міхура називають
А анурією В уретритом Б циститом Г пієлонефритом
4. Підшкірна жирова клітковина забезпечує
А збереження теплоти в організмі Б регуляцію теплообміну в організмі В виділення рідких продуктів обміну Г виділення на поверхню шкіри
5. Структура шкіри, яка забезпечує сприйняття подразнень, — це А сальна залоза В рецептор Б потова залоза Г капіляр

6. Правильний перелік складників організму, які здійснюють видільну функцію, наведено в рядку А нирки, серце, шлунок В нирки, спинний мозок Б потові залози, печінка Г сальні залози, нирки
Тестові завдання з однією відповіддю (1 бал)
7. Проаналізуйте твердження щодо наведеного зображення нефрона. І. Цифрою 1 позначено звивистий каналець.
ІІ. Цифрою 2 позначено збірну трубочку.
Чи є поміж них правильні?
А правильне лише І
Б правильне лише ІІ
В обидва правильні
Г немає правильних
8. Ознайомтеся з переліком

9. Ознайомтеся з підписами складників шкіри, які позначено буквами (А – Г).
Який підпис зроблено ПОМИЛКОВО?
А капіляр
Б рецептор
В сальна залоза
Г волосяна сумка
Тестові завдання з однією відповіддю (1,5 бала)

10. Прочитайте опис: «Частина нефрона, у якій відбувається реабсорбція, — це (1). Унаслідок цього процесу у кров повертається (2)». Правильний варіант для заповнення пропусків (1–2) наведено в рядку
А 1
капсула нефрона, 2 глюкоза
Б 1 капсула нефрона, 2 сечовина
В 1 звивистий каналець, 2 сечовина
Г 1 звивистий каналець, 2 глюкоза 11. Учень і учениця
що в шкірі може утворюватися вітамін
буквами А – В.
Оберіть правильні твердження.


Представників видів, органами виділення

§ 40. Сенсорні системи й чутливість
Реагування на подразники починається з активації чутливих рецепторних структур. Залежно від подразників, виокремлюють фоторецептори (сприймають світло), механорецептори (механічні впливи: тиск, дотик, слух, рівновага, чутливість тіла), хеморецептори (хімічні речовини), терморецептори (температура). Окремо говорять про больові або ноцицептори, проте цікаво, що окремих больових подразників не існує (див. § 47).
Будова сенсорних систем. Основою пристосування організму до змін є сприйняття та аналізування інформації про навколишній світ і формування за результатами програми дій. Структури, які сприймають та аналізують інформацію, називають сенсорними системами. В організмі людини виокремлюють зорову, слухову, вестибулярну (рівноваги), смакову та нюхову сенсорні системи (іл. 164). Також ми сприймаємо та аналізуємо сигнали від власного тіла: шкіри, м’язів, сухожилків і внутрішніх органів, що є функцією соматовісцеральної системи. У складі кожної сенсорної








відчуття те, що ми бачимо, чуємо або сприймаємо
Робота рецепторів. Подразнення безпосередньо сприймаються чутливими структурами рецепторами. Ними можуть бути закінчення сенсорних нейронів (шкірна чутливість) або спеціалізовані клітини (слухові, зорові рецептори тощо). Рецептори кожного типу найкраще пристосовані до сприйняття подразників лише певного типу. Для фоторецепторів ока таким є світло, для нюхових хімічні речовини в повітрі, для терморецепторів
температури. У відповідь на стимул рецептори генерують електричні сигнали, які далі нервовими клітинами передаються до центральної нервової системи. Для їх виникнення необхідна мінімальна кількість енергії подразника цю кількість називають порогом сприйняття. Що сильнішим є вплив на рецептор, то більше нервових імпульсів прямує провідниковими структурами. Саме так у нервовій системі закодована інтенсивність стимулів (іл. 165). Просторове кодування сенсорної інформації. Шляхи передавання збудження в різних сенсорних системах не перехрещуються, а кінцеве аналізування здійснюється різними ділянками головного мозку (іл. 166). Отже, у тому, якими нервовими шляхами передається збудження, закодована інформація про тип подразника (світло, звук, дотик та ін.).
Іл. 166. Принцип просторового кодування




чутливості шкіри й тулуба
► зорова
► слухова
► вестибулярна
► смакова
► нюхова
таке навряд чи можливо, але якщо казати
усвідомлювану інформацію, це може бути близьким до істини. Периферійна частина зорової сенсорної системи представлена
яблуком і допоміжним апаратом ока. Будова ока. Очне яблуко розташоване в заглибленні черепа
ямці. Ознайомимося з його будовою (іл. 167). Зовнішній шар очного яблука представлений сполучнотканинною оболонкою, у якій виокремлюють задню частину склеру і передню прозору рогівку. Вони захищають око від ушкоджень. Під склерою розташована судинна
розташований кришталик прозорий утвір, за формою і функціями
кришталиком задньою


ховими м’язами, повіками та віями. Слізний апарат має слізну залозу. Сльоза зволожує поверхню ока, сприяє видаленню чужорідних тіл і містить протибактеріальну речовину лізоцим. Шість м’язів забезпечують рухи очного яблука, що є необхідним для стеження за об’єктами навколишнього середовища. Повіки захищають око, сприяють вимиванню сльозою чужорідних тіл і зволоженню. По краях повік розташовані вії, які також виконують захисну функцію. Око як оптичний прилад. Світло, що його випромінюють об’єкти довкілля або що відбивається від них, проходить крізь рогівку, передню камеру ока та кришталик. Перелічені структури працюють як лінзи, заломлюючи світло. Далі воно прямує
Іл. 168 Акомодація ока

Сформулюйте мету та складіть план лабораторного дослідження акомодації ока. Дослідіть фокусування зображення: а) на близьких і далеких об’єктах; б) під час роботи з мікроскопом. Акомодація може порушуватися: розрізняють міопію («близькозорість»), гіперопію («далекозорість»)
вішим і цікавішим. Фоторецептори. Фоторецептори
й колбочки. Паличок набагато
і 6–7 млн відповідно). Колбочки
частині сітківки,
(іл. 169). Механізм сприйняття


клітини електричного сигналу. Він поширюється до синапсу, де спричинює вивільнення медіатору, який впливає на сполучені нервові клітини. Нейромережі сітківки утворені нейронами багатьох типів і забезпечують початкове аналізування зорової інформації. Його результатом
нервових імпульсів, які
ного мозку. Фоторецептори здатні адаптуватися до кількості світла, що потрапляє до ока. За денного яскравого освітлення їхня чутливість знижується (це називають світловою адаптацією). Коли
приміщення, спочатку світла недостатньо, і ми майже нічого не бачимо. За деякий час чутливість повертається
рівня
добре бачимо.
Сприйняття кольорів. Зорові пігменти різних фоторецепторів неоднакові за будовою та функціями. У паличках вони однакові, а зорові пігменти колбочок
нашої здатності розрізняти кольори
Центральна обробка зорової інформації. Зорові нерви прямують
(іл.
що ближче
до вух. Відростки нейронів зовнішньої частини сітківки
розміщеної з того самого
дення лабораторного дослідження (іл. 173).
Від таламуса
півкуль (іл. 172), де здійснюється подальша обробка зорової інформації. Вона багатоетапна: спочатку виділяються прості характеристики, як-от лінії та кути, а далі з них усе складніші й складніші форми. Виокрем-
люють дві підсистеми подальшого аналізування зорової інформації.
Система «Що» пов’язана зі скроневою корою, де обробляється інформація
про об’єкти, їхні форми та кольори. Завдяки їй ми розпізнаємо та можемо назвати знайомі речі. Система «Де» пов’язана з тім’яною корою та відповідає за визначення розташування об’єктів у
їхніх
і рухів відносно нас («зір


(іл. 175). Зовнішній слуховий
стінці є багато сальних залоз, які продукують
сірку», до складу якої входить, зокрема, лізоцим, тому вона виконує захисну функцію. Канал завершується барабанною перетинкою пружною мембраною, що відділяє зовнішнє вухо від середнього. Середнє вухо це заповнена повітрям порожнина, у якій розташовані слухові кісточки: молоточок, коваделко та стремінце (іл. 175). Вони з’єднані між собою за допомогою суглобів та утворюють систему фізичних важелів.


собою закручену структуру, діаметр якої зменшується в напрямку від основи до верхівки. Усередині порожнина завитки
три заповнені рідиною канали, розділені двома мембранами: основною і присінковою. Ключові процеси сприйняття звуків забезпечуються слуховими рецепторами, розташованими на основній мембрані. Вони входять до складу спеціалізованої структури кортієвого органу (іл. 176).
Сприйняття звуків. Рухи стремінця крізь мембрану овального вікна спричиняють коливання рідини, що нею заповнені канали завитки. Своєю чергою, ці коливання перетворюються на
коливання основної мембрани, на якій розташовані слухові рецептори волоскові клітини. Їхньою особливістю є численні вирости мембрани, направлені в порожнину центрального каналу.
торкаються драглистої структури покривної
основної
рани приводять до відхилення волосків рецепторів у напрямку або
центральної осі, або до периферії завитки. Що гучніше звук, то сильніше коливається основна мембрана, сильніше відхиляються волоски, на рецепторах розвивається більше збудження (іл. 177).
Іл. 176. Будова кортієвого органу
Присінкова мембрана Покривна мембрана


редніх колінчастих ядер
реакції,
тувальні рефлекси на нові, неочікувані звуки,

клітини. Обертання голови в різних площинах унаслідок інерційності спричиняє рух рідини, що заповнює канали. При цьому волоски відхиляються у відповідному напрямку (іл. 181). Півколові канали розташовані в трьох
кожного з них найкраще реагують на обертання голови в одній
Отже, чутливі клітини камер реагують
в просторі, а рецептори
повороти й нахили).
Значення вестибулярної інформації. Від рецепторів
імпульси вестибулярною гілочкою присінково-завиткового
до стовбуру. Вестибулярна інформація
функціонування організму. Крізь
для усвідомленого відчуття
рухів. Важливою структурою,
інформацію, є мозочок. Він забезпечує координацію
коли ми крутимо головою. Також вестибулярні ядра надсилають
нейронів спинного мозку, що забезпечує рефлекторну підтримку пози.
Іл. 180. Принцип роботи камер вестибулярного апарату (сприйняття сталого положення голови)

Іл. 181. Принцип роботи півколових каналів вестибулярного апарату (сприйняття обертань голови)


й ідентифікувати наявні в повітрі леткі
нини (іл. 182). Із повітря молекули пахучих сполук
на поверхні цих клітин, які містять чутливі білки. Активація
системи, де відбувається аналізування інформації, розташована
Іл. 182. Розташування нюхових рецепторів
Нюхова цибулина
Нюхові нерви
Носова порожнина

Іл. 183. Чутливі клітини нюхової сенсорної системи

Перемикальні нейрони
ділянках лобової частки, які розміщені на
мозку поблизу очних ямок (див. §9, іл. 40).
Смакова сенсорна система. Ця сенсорна система також аналізує хімічні речовини, але ті, що впливають на слизову оболонку язика. На ньому розташовані сосочки, де формуються смакові цибулини з чутливими клітинами (смаковими рецепторами) (іл. 184). Розрізняють п’ять основних смаків (іл. 185). Кислий смак пов’язаний із кислотністю розчинів, що впливають на язик. Чистий солоний смак має харчова сіль. Найрізноманітнішими за хімічною будовою є солодкі та гіркі речовини. Солодкий смак мають здебільшого цукри, тобто їжа, яка є джерелом енергії. Натомість гіркий смак мають продукти розпаду (гниття) білків та інші отруйні речовини. Наявність їх у їжі свідчить про її небезпечність. Смак юмамі (умамі) визначається наявністю в розчині певних амінокислот, він пов’язаний зі смаком білків і м’ясних продуктів. Від смакових рецепторів збудження передається до стовбурових центрів у складі аж трьох нервів: лицевого, язикоглоткового і блукаль-
ного. Далі воно прямує до таламуса, звідки передається до смакової кори, яка розташована поруч із частиною соматосенсорної кори, що відповідає
за язик (див. § 9, іл. 40).
Описані вище п’ять базових смаків, зрозуміло, не можуть пояснити все розмаїття смаків їжі. Це зумовлено тим, що під час жування й ковтання частина повітря з ротової порожнини потрапляє до носової та стимулює нюхові рецептори (іл. 182). Комбінація смакового
при цьому формує
Іл. 184. Чутливі структури






гомункулюсом (іл. 188).
Соматовісцеральна система. Ця сенсорна система
тури, периферійна частина яких розташована в шкірі і м’язах (соматична) та внутрішніх органах (вісцеральна чутливість).
Шкірна чутливість. Певно, більш знайомими є форми шкірної чутливості: тактильна (дотик, тиск), температурна і больова. Рецепторна частина цієї системи представлена закінченнями чутливих нейронів. Вони можуть вільно закінчуватися
спеціальними капсулами. За розташуванням
рецептори, закінчення яких
дерми, та глибинні, розташовані
сумок. Відчуття дотику й тиску забезпечують механорецептори,
яких виокремлюють кілька типів (іл. 186).
розташування рецепторів у шкірі
чутливість
Іл. 186. Різноманітність
рецепторів
Вільні нервові закінчення (біль, температура)
187. Вимірювання
Волосина
Диски Меркеля (тиск, рельєф) Епідерміс
Тільця Мейснера (швидкий дотик, тремтіння)
Рецептори

волосяних сумок (швидкий дотик, тремтіння)
Чутливі
Закінчення

що має важливе значення для керування рухами (див. § 8, іл. 33). Больова чутливість, або ноцицепція. Це особливий тип чутливості, оскільки не існує специфічних больових подразників. Больові відчуття можуть бути викликані чинниками різної природи високою або низькою температурою, зміною хімічного складу міжклітинної речовини при запаленнях або інших патологічних станах, пораненнях тощо. Гострий біль виникає відразу при порушенні цілісності тканин (наприклад опік або поріз) і швидко проходить. Отже, він уможливлює швидке інформування про ураження організму. Повільний біль триває довше, його інтенсивність менша. Такий біль може, зокрема, обмежувати різноманітні впливи на уражені ділянки організму під час загоєння ран. Центральне оброблення інформації. Збудження
соматовісцеральної системи надходить до центральної нервової системи крізь задні роги спинного мозку (див. § 8, іл. 31) або в складі чутливих черепно-мозкових нервів: за
трійчастий нерв, а за більшу частину чутливості внутрішніх
блукальний (див. § 9, іл. 36). На шляху до кори збудження проходить крізь таламус. Соматосенсорна кора розташована в зацентральній звивині тім’яної частки (іл. 188). Вивчення функціонування сенсорних систем дозволяє нам



білки безпосередньо сприймають
напруженості, натягнення плазматичної мембрани, що обумовлює формування нервового імпульсу. Білки PIEZO також можуть бути штучно активовані хімічними сполуками. Хто знайомий із всесвітом Зоряних Війн,
чому для хімічних активаторів білків, які реагують на прикладання сили, були обрані
(дивись рисунок).

Білків Piezo стимулом механічні впливи на мембрану є. За допомогою хімічних сполук бути активованими також вони можуть. Два активатори білка Piezo1 науковцям відомі: Yoda1 та Jedi2.
Виконайте тестові завдання.
Завдання 1. Для роботи
Piezo?
А фоторецептори В терморецептори Б хеморецептори Г механорецептори
Завдання 2. Сенсорні функції
боти білків Piezo?

1. Частину

2. Акомодацію ока забезпечує А рогівка В кришталик Б сітківка Г склисте тіло
3. Клітинами, які сприймають звукові
є А волоскові клітини завитки Б клітини сітківки колбочки В клітини сітківки палички Г волоскові клітини носової порожнини
4. Рецептори півколових каналів уможливлюють сприйняття
А обертання голови В якості харчових продуктів Б сили звукових сигналів Г кольорів навколишніх об’єктів
5. Оберіть правильну пару «сенсорна система — рецептори». А зорова механорецептори В слухова фоторецептори Б смакова хеморецептори Г вестибулярна терморецептори
6. У якій частині кори півкуль головного мозку міститься центральна частина нюхової сенсорної системи? А лобовій В скроневій Б тім’яній Г потиличній
Тестові завдання з однією відповіддю (1 бал)
7. Роздивіться рисунок і проаналізуйте твердження. І. На рисунку буквою А позначено сітківку.
ІІ. На рисунку буквою Б позначено кришталик. Чи є поміж них правильні? А правильне лише

9. На уроці учень зробив підписи до рисунка. Який підпис зроблено ПОМИЛКОВО?
А Барабанна перетинка
Б Кортіїв орган
В Молоточок Г Завитка
Тестові завдання з однією відповіддю (1,5 бала)

10. Прочитайте опис: «Нюхова сенсорна система сприймає (1) подразнення за допомогою рецепторів, які розташовані в (2)». Замість цифр у речення необхідно вписати слова.
Правильний варіант наведено в рядку
А 1 світлові, 2 сітківці
Б 1 хімічні, 2 носовій
В 1 звукові, 2 кортієвому
Г 1 хімічні, 2 півколових
11. Учень й учениця на уроці обговорювали будову
що шкірна чутливість, зокрема
ся механорецепторами.
Чи має хтось із них рацію?
А лише учень
Б лише учениця
В обоє мають рацію
Г обоє помиляються
Тестове завдання з однією відповіддю в
стовпчику (3 бали) 12. Розгляньте рисунок, на якому буквами (А – Д) позначено складники вуха людини.
Укажіть правильні твердження.


і математик Рене Декарт (іл. 189). У своїй праці «Трактат
людину» (1664), він описав рефлекси як автоматичні
зовнішні стимули, які здійснюються без участі свідомості. Декарт уявляв, що сигнали, які він називав тваринними духами, рухаються нервовими волокнами, подібно до води в трубах, і автоматично викликають відповідні рухи в м’язах. Хоч зараз ми знаємо, що нерви і м’язи працюють не так, його ідеї стали основою для подальших досліджень нервової системи й
сенсорної інформації, а також керування роботою
та зовнішні стимули, що виражаються як
печують поведінку, називають
тощо (іл. 190).
189. Рене Декарт

фізіологічних
раніше рефлекторним принципом (іл. 191). Виокремлюють вроджені (генетично зумовлені) та набуті протягом життя форми поведінки.
Вроджена поведінка. Основною формою вродженої поведінки є безумовні рефлекси.
Безумовні рефлекси вроджені однотипні в усіх особин одного
виду відповіді організму на певні подразники.
Вроджена поведінка забезпечує пристосувальні реакції у відповідь на
контакт
оскільки може призвести до опіку, внаслідок якого
нізму можуть загинути.
від гарячого є завжди пристосувальною. Безумовні реакції до певної міри можуть контролюватися свідомістю. Наприклад, якщо неочікувано гарячий предмет, що ми взяли в руку, це дорога для нас порцелянова чашка, рефлекторний імпульс відкинути її може бути загальмованим, і ми поставимо чашку на стіл, аби не розбити (іл. 192). Безумовні рефлекси можуть бути: простими (колінний рефлекс), складними багатокомпонентними (жування, чхання тощо), надскладними, до яких відносять інстинкти.
Іл. 191. Принцип здійснення рефлексів
Іл. 192. Гальмування імпульсивної поведінки

направлену
розглядають як інстинкт самозбереження. Материнський (батьківський) інстинкт направлений на догляд за немовлям та
захист
(іл. 194). Частково інстинктивною є гігієнічна поведінка, що ґрунтується на вродженій емоційній реакції відрази. Ми є соціальними істотами, тому нам властиві об’єднання в групи, взаємодія з іншими, взаємодопо-
мога, що становить соціальний інстинкт.
Приклади безумовних рефлексів. Як безумовні, так і умовні (які ми розглянемо в наступному параграфі) рефлекси класифікують за біологічним значенням. Захисні рефлекси
гання ушкодження організму: відсмикування
кліпання
або примруження, сльозовиділення, кашель, чхання тощо. Харчові рефлекси направлені на здобуття
забезпечують процеси травлення: смоктання, слиновиділення, секреція


два нейрони, складніші більше. Замикання рефлексів
здійснюватися на різних рівнях нервової системи. Чимало з них контролює спинний мозок (рефлекси розтягнення м’язів, відсмикування кінцівок, сечовипускання, дефекації тощо). Низка рефлексів замикається на рівні стовбуру головного мозку (ковтання, чхання, слиновиділення, підтримка пози, рухи очей тощо). Ці структури контролюють переважно безумовні рефлекси. Інстинктивна поведінка та умовні рефлекси більшою мірою пов’язані з роботою вище розташованих проміжного та кінцевого мозку (іл. 195).
Поведінка й нервові процеси. Активація виконувальних структур пов’язана зі збудженням відповідних нервових центрів. Проте в здійсненні як рефлексів, так і складніших
поведінки важлива роль належить процесам гальмування. Для коректного здійснення
а й загальмувати їхні антагоністи. У багатьох випадках симпатичний і парасимпатичний відділи автономної нервової системи працюють як антагоністи, тому активація одного з них супроводжується гальмуванням іншого. Наприклад, поведінка за типом «боротьба або втеча» в небезпечних

їжа,
реакція слиновиділення. За допомогою умовних рефлексів організм ніби передбачає майбутнє й реагує на важливі стимули завчасно. Умовнорефлекторне виділення слини та шлункового соку готує травну систему до надходження невдовзі їжі, процес травлення стає швидшим і ефективнішим. Подібні рефлекси формуються і в нас. Чи помічали ви виділення слини, коли чуєте з кухні звуки приготування їжі або сервірування столу? Окрім збігу в часі, є й інші умови формування таких рефлексів. Зокрема, нейтральний подразник повинен бути помітним для організму, але не надто сильним. Якщо в прикладі із собакою замість дзвоника ми використаємо автомобільну сирену, то спостерігатимемо захисний рефлекс (сховатися), а слиновиділення загальмується. Значення має стан організму: слиновидільний рефлекс добре виробляється в голодного собаки й не буде утворюватися в нагодованого. Швидкість формування умовних рефлексів залежить від типу подразника. Захисні реакції можуть розвиватися навіть при одноразовому поєднанні нейтрального стимулу із сильним больовим подразником. Чинники інших типів можуть вимагати кількох десятків поєднань. Типи умовних рефлексів. Подібно
класифікують за біологічним значенням.
Іл. 197. Схема формування умовного





швидше і частіше. Інструментальна поведінка є складнішою та більше
подібна до природної.
Механізм формування умовних рефлексів.
нейтрального, так і значущого
збудженням



слину? У такому випадку умовнорефлекторна
зменшується, це називають згасанням умовного рефлексу. При цьому він не зникає повністю, оскільки в разі відновлення поєднання нейтрального та значущого стимулів рефлекс проявиться швидше, ніж він утворювався вперше. Ключову роль у припиненні неактивних рефлексів відіграють процеси гальмування. В описаному випадку говорять про згасальне гальмування. Умовні рефлекси також можуть блокуватися сильнішими подразниками як-от больові або згадана вище автомобільна сирена. Цікавим є умовне гальмування поведінки, коли певний стимул сам по собі підкріплюється безумовним подразником, а в поєднанні з іншим ні. Вид і запах їжі може бути чинником запуску харчової поведінки собака чи кішка можуть «вкрасти» її зі стола. Присутність же господаря (який сваритиме за це) є гальмівним сигналом. Значення умовних
нейтральними та важливими сигналами дає змогу організмові
на випередження, реагувати більш ефективно. Завчасний розвиток захисних реакцій може запобігти


явища пов’язані
й себе самої. Спрощено їх можна уявити
те, що приводить
відчуттів, і уникати того, що пов’язано з негативними переживаннями. Регуляцію емоційних реакцій здійснює низка структур головного мозку, головні з яких належать до лімбічної системи (див. § 9).
Пам’ять та навчання. Пам’ять здатність особини
відтворювати інформацію, яка зумовлена роботою
пам’яттю тісно пов’язане




збудженням клітин відповідних
Завдяки цьому, наприклад, ми практично не відчуваємо затемнення під час кліпання очима. Короткочасна пам’ять триває кілька секунд або хвилин. Її обсяг обмежений і становить приблизно 7 (± 2) одиниць інформації. Із короткочасної пам’яті інформація може переходити до довготривалої, яка триває кілька годин, діб, років і навіть усе життя. Такий процес ми називаємо запам’ятовуванням. Стійкішими є спогади автобіографічного характеру. За типом інформації, яку запам’ятовують, розрізняють зорову, слухову, тактильну, смакову форми пам’яті тощо. У найменшому ступені ми здатні пригадувати запахи, оскільки нюхова сенсорна система не має настільки потужного коркового представництва порівняно з іншими. Нюхова пам’ять зазвичай здійснюється за принципом розпізнавання наявних стимулів («чим пахне?»). Ми не можемо чітко уявити певні аромати, натомість можемо легко відтворити зорові (наприклад, уявити стілець), слухові (подумки відтворити знайому
та інші образи. Особливості довготривалої пам’яті. За фізіологічними механізмами виокремлюють






півкуль унаслідок процесів синаптичної пластичності (див.
6). Різні форми пам’яті залучають різні мозкові структури,
значення мають асоціативні ділянки кори. Прихована, неявна пам’ять також є результатом навчання, але ми не можемо виразити її словами (іл. 201). Одним з її типів
пам’ять рухові навички й вміння (іл. 202). Наскільки б детально ми не розповідали, як їздити на
тися цього можна лише самостійно виконавши ці
умовних рефлексів.
до явної, у формуванні
пам’яті ключова роль належить синаптичній пластичності, але в інших мозкових структурах. Зокрема, рухова пам’ять пов’язана з мозочком та основними ядрами кінцевого мозку (див. § 9), а емоційна з лімбічною
системою (іл. 202).
Робоча пам’ять. Читаючи текст,
роботу,
слова


ційного перенасичення
підлягає здебільшого важлива для життєдіяльності інформація. Одним із механізмів оцінювання цієї значущості є емоції. Ми краще запам’ятовуємо те, що викликало позитивні чи негативні хвилювання. Проте в деяких випадках ми можемо повністю забувати
у
спосіб мозок захищає себе від надмірного емоційного збудження. Процеси синаптичної пластичності, що лежать в основі запам’ятовування, залежать від інтенсивності використання тих чи інших синапсів. Ті, що працюють частіше, підтримуються активними, а проходження ними інформації відбувається швидше (іл. 203). Не марно кажуть: «Повторення мати навчання». Синаптична пластичність дає нам змогу вчитися нового. Для збереження навичок нейронні ланцюги, які їх забезпечують, потрібно підтримувати активними. Інформація, якою ми не користуємося, або навички, які ми не тренуємо, згасають. Увага. Кожної

допомагає організовувати потік інформації, щоб ефективно виконувати завдання, розв’язувати проблеми та приймати рішення.
Розрізняють дві форми уваги. Довільну увагу можна розуміти як певний фільтр сенсорної інформації, вона проявляється у вибірковому гальмуванні деяких не важливих на цей момент сенсорних потоків і вибірковому посиленні інших важливих. На них ми зосереджуємося, концентруємо увагу. Наприклад, якщо ми із захопленням читаємо книгу, то можемо не помічати розмов навколо нас, змін температури повітря, легких дотиків тощо (іл. 204). Проте якщо поряд хтось почне розмовляти дуже голосно, то, скоріше за все, ми відволічемося від книги і звернемо увагу на новий інтенсивний подразник. Це є
форми
тувальний рефлекс. Особливості роботи мимовільної

сигнал приблизно раз
хвилину
тривалості (30–90 с), процес повторюється 20–30 разів. Через 3 с після початку сигналу «піддослідний/на» долонею затуляє одне око, а іншим дивиться на «експериментатора/ку». «Експериментатор/ка» спостерігає за змінами діаметра зіниці відкритого ока, занотовуючи час її розширення після затуляння ока або до нього. Що зі спостереженого є безумовним рефлексом (див. § 44), а що умовним? Після скількох поєднань звуку із затемненням ока розвинувся умовний рефлекс? Емоційне вираження Перша наукова праця з вивчення емоцій належить англійському природодосліднику Чарльзу Дарвіну. Він відзначив подібність емоційного вираження в людей і тварин, що вказує на еволюційне походження таких реакцій. У своїй праці він ґрунтовно дослідив рухи, пов’язані з різними емоціями, і вказав на пряму роль нервової системи в їх розвитку. Дарвін визначив шість базових емоцій: лють, страх, подив, відраза, щастя та журба. Єдиного підходу до класифікації емоцій наразі не існує, різні дослідники виділяють від чотирьох до кількох десятків.
Учні та учениці об’єднуються в пари. Завданням одного є зобразити в довільному порядку різні емоції з переліку Дарвіна, а іншого розпізнати їх, занотувавши по порядку. Потім можна помінятися ролями.
Короткочасна пам’ять
Учитель/ка зачитує вголос послідовності двозначних чисел довжиною від 3 до 10 елементів. Через три секунди після завершення читання учні й учениці записують продиктовані числа. По завершенні запису останнього ряду їх зачитують ще раз для перевірки. Обсягом короткочасної пам’яті вважають кількість елементів у ряді, що був повністю правильно відтворений перед першим рядом з помилкою. Довготривала асоціативна пам’ять На початку уроку учитель/ка зачитує
почергово 10 словосполучень, що складаються
§ 49. Фізіологічні основи мовлення
Значення мови в еволюції людства важко переоцінити. Більшість думок та ідей, які ми називаємо свідомими, можуть бути виражені словами. Спогади, які можна сформулювати за допомогою слів, утворюють явну підсистему пам’яті. Використання мови дозволяє передавати знання між різними поколіннями (іл. 205).
Дві сигнальні системи. Як уже було наголошено, функцією сенсорних систем є сприйняття
аналіз і формування відчуттів внутрішніх образів сенсорних сигналів. Описану сукупність процесів називають першою сигнальною системою. Окрім таких безпосередніх стимулів
зараз прочитали, представлене
точок, які разом є зоровим подразником. Проте нервова система
творює його на поняття «звук».
сигнальну систему
нікації сигнали, які позначають певні поняття. Мова. Проявом

та структури головного мозку. У забезпеченні здатності
мозку (іл. 206). Зона Верніке або слуховий центр мови
але не розуміє чужих слів і не здатна складати осмислені
звивині. Вона контролює мовленнєві рухи,
правильно говорити. Її пошкодження супроводжується труднощами у вимові слів і формуванні граматично правильних речень, хоча розуміння мови залишається відносно збереженим. Обидві
тісно функціонально пов’язані між собою.
букв і слів. Розташована поблизу моторного центру







психіки є свідомість. Свідомість це внутрішнє відображення оточення, усвідомлення себе та свого положення у світі, розуміння закономірностей взаємозв’язків себе з навколишніми об’єктами.
Свідомість і мислення. Поняття «свідомість» має кілька складників. Зокрема, ми говоримо про усвідомлене
інформації. У цьому важливу роль
міжособової
процес називають мисленням. Його складниками є: виділення
характеристик аналіз, об’єднання різних характеристик синтез, порівняння, класифікація, абстрагування тощо (іл. 207). Здатність людини до мислення, навчання, розв’язування проблем, адаптації до нових ситуацій
сприйняття нами нас самих як індивідуальностей. Мозкові структури, що забезпечують самоусвідомлення, були виявлені в результаті узагальнень експериментів зі скануванням мозку (іл. 208). Зазвичай дослідники порівнюють роботу мозку в стані спокою та
процесі виконання певного завдання. Учені помітили, що при цьому спостерігається не лише активація специфічних для завдання ділянок головного мозку, а й зниження активації деяких інших. При цьому характер такої інактивації був подібним, незалежно від типу завдання, яке виконувала людина. Тобто підтримання роботи мозку в стані спокою, коли ми нічим не зайняті, але не спимо, саме по собі є мозковою функцією, за яку відповідають нейромережі спокою. Головними складниками цих мереж є структури головного мозку, залучені до самоусвідомлення (іл. 208). Розлади цих структур пов’язані з низкою психіатричних і неврологічних хвороб. Свідомість як стан мозку. Також про свідомість говорять у вужчому значенні, характеризуючи стан людської психіки. Її відсутність визначають як непритомність. На противагу виділяють нормальний, притомний, свідомий стан. Зміни свідомості, за яких людина не відчуває себе як суб’єкта або таке відчуття суттєво відрізняється від «звичайного» стану, можуть виникати як унаслідок природних
штучних чинників. Головним
Іл.

Усі ми багато разів переживали таке явище, як сон. Цей змінений стан свідомості часто супроводжується внутрішніми переживаннями, які ми називаємо сновидіннями. Цікаво, що
стани притаманні й іншим тваринам (іл. 209). Ми не можемо точно знати, чи сниться їм щось та як виглядають їхні сни, але низка фізіологічних ознак вказує на тотожність пов’язаних із цим мозкових станів.
Характеристика сну. Сон є прикладом існування в організмі людини циклічних процесів біоритмів. Ритмічні
й триваліші біоритми,
цикл у
чому організмі, про які йтиметься в наступній темі. Під час сну поведінкова активність знижується, ми мало рухаємося, не реагуємо на більшість сенсорних подразників, наші дихання, кровообіг і травлення сповільнюються, дещо зменшується температура тіла. Традиційно




цього є зменшення активності м’язів, уповільнення серця та дихання тощо. Структура сну. Дослідження активності головного мозку дозволили виділити дві головні фази сну: повільний, або глибокий, сон, коли людину найважче розбудити, та фазу швидких рухів очима, коли людина переживає сновидіння. Під час швидкого сну очі заплющені, але очні яблука рухаються, ніби стежачи за якимись об’єктами. Водночас м’язи тіла перебувають у максимально розслабленому стані, а електрична активність мозку нагадує активність під час неспання (іл. 210). Тому цю фазу ще називають парадоксальним сном. У людини глибокий сон додатково поділяють на кілька стадій. Під час звичайного нічного сну
відбувається три-чотири чергування обох фаз (іл. 210). Уважають, що ми бачимо сновидіння
прокидання можемо пам’ятати лише останній. Надійну реєстрацію фаз сну здійснюють за допомогою електроенцефалографу приладу, що вимірює електричну активність головного
мозку, окорухових м’язів тощо (іл. 211). Сучасні мобільні прилади, як-от розумні годинники або фітнес-трекери на основі різних параметрів також розподіляють сон на активний і неактивний. Проте принаймні поки що їхня класифікація дуже неточна, достатньо надійно визнача-
Іл. 210. Структура сну


кору. Тому зазвичай у шумному приміщенні погано спиться.
коли зовнішніх подій мало, збуджувальний
як би гучно навколо нас не було, якщо ми вкрай стомлені, то рано чи пізно сон нас зморить. Причиною цього є накопичення
тканині головного мозку продуктів обміну речовин,
специфічні





ефект. Значення сну. Сон є важливим складником життєдіяльності людини. Під час сну відбуваються процеси формування довготривалої пам’яті. Також з нервової тканини видаляються продукти обміну речовин, що сприяє працездатності мозку та запобігає розвиткові неврологічних хвороб. Тривале позбавлення можливості спати супроводжується зниженням працездатності, розвитком утоми, дратівливості, а в разі дуже тривалого неспання провалами в пам’яті, головним болем, запамороченням, галюцинаціями, сенсорними розладам тощо. Регулярне недосипання є чинником розвитку стресу. Для забезпечення здорового сну потрібно дотримуватися кількох простих рекомендацій (іл. 213). Лягати спати й прокидатися треба в той самий час щодня, навіть у вихідні. У спальні потрібно забезпечити комфортну температуру, тишу та темряву. Перед сном не варто користуватися пристроями з яскравими екранами. Світлозалежні механізми регуляції сну більшою мірою активуються синьою частиною спектру, тому в багатьох пристроях є можливість увімкнення нічного режиму коли екран випромінює менше синього, «тепліші» кольори. Це
сном треба уникати значної
Регулярні фізичні
уникати інтенсивних навантажень перед сном. Іл. 213 Гігієна

Домінування
кров — сангвінік (веселий, енергійний), лімфа — флегматик (спокійний, повільний), жовта жовч — холерик (гарячковий, запальний), чорна жовч —
меланхолік (сумний, задумливий). Ця теорія мала великий вплив на медицину та психологію протягом століть, хоча сучасна
її не підтримує.
Незважаючи на те, що кожна людина є унікальною




між збудженням і гальмуванням. На основі комбінацій цих властивостей виділяють чотири типи темпераменту (іл. 214). Сангвініки мають сильний, урівноважений, рухливий тип нервової системи, швидко адаптуються, є оптимістичними й активними. Флегматики також сильні та врівноважені, але водночас інертні, вони погано перемикаються між різними типами діяльності. Холерики мають сильну неврівноважену нервову систему, вони імпульсивні, енергійні, схильні до різких змін настрою. Меланхолікам притаманний слабкий тип нервової системи, вони вразливі, схильні до тривог і переживань, швидко втомлюються. Незважаючи на використання тих самих назв темпераментів, що й у гуморальній теорії, цей підхід, безперечно, більш біологічний. Велика п’ятірка. Сучасна психологія виділяє «велику п’ятірку» індивідуальних рис людини (іл. 215). Відкритість до нового досвіду характеризує допитливість і готовність до змін, креативність, схвальне сприйняття мистецтва, емоцій, пригод, незвичайних ідей, цікавість і різноманітність досвіду. Сумлінність це тенденція бути організованими та надійними, демонструвати самодисципліну, діяти слухняно, прагнути до досягнення
танній поведінці.
Іл. 215.



які є
сором’язливими і застереженими. Доброзичливість це тенденція більше співчувати та допомагати людям,
тися та ворожо ставитися до інших. Це також є показником довірливого і альтруїстичного характеру, а також показником доброго виховання. Нейротизм схильність до психологічного стресу, здатність легко відчувати неприємні емоції, як-от
вість. Часто нейротизм називають емоційною стійкістю.
стійкість проявляється як стабільна і спокійна особистість, але її можна розглядати як незворушливу та байдужу. Низька стабільність проявляється як реактивна і збудлива особистість, часто трапляється
індивідів, але може сприйматися як
або небезпечна.
того, люди з більш високим рівнем нейротизму зазвичай мають
психологічне благополуччя. Як бачимо, ця класифікація ґрунтується
особистості, що, відповідно, зумовлює
багато

особливості пов’язані з переважанням тієї чи іншої півкулі в процесах оброблення інформації. Ліва зумовлює математичні здібності, логіку, міркування, аналітику тощо. Права сприйняття і створення музики, художніх образів, переживання емоцій тощо (іл. 216). Таке спрощене уявлення не має наукового підтвердження. У здорової людини обидві півкулі інтенсивно обмінюються інформацією, більша частина якої проходить крізь мозолисте тіло. Тому опрацьовування інформації різного типу здійснюється обома півкулями. Виняток становить сприйняття
про що йшлося вище. Дещо активнішою є ліва півкуля
здійснення математичних обчислень, але це пов’язують також з її мовленнєвою функцією. Індивідуальність і вибір професії.
навичок. Для певних професій
багато спілкуватися з іншими людьми, організовувати їх у колективи, уміти працювати командою. Десь критичною є стресостійкість, а десь творчі навички. Відповідність індивідуальних особливостей
роботу ефективнішою, а життя комфортнішим. І навпаки на посаді, що не відповідає індивідуальним схильностям, людина буде нещасливою та неефективною. Існує чимало підходів до визначення персональних
професійних схильностей.
Лабораторний практикум
Існують різні методи визначення професійних схильностей. Одним з них є тест
американського науковця Джона Герні Голланда — опитувальник професійного самовизначення. Цей тест дозволяє співвідносити схильності, здібності із вимогами до певних



Аналізуємо інформацію, робимо висновки Ознайомтеся з інформацією та виконайте тестові завдання.
Пам’ять і морський коник
Подекуди цілі розділи науки починаються з вивчення унікальних випадків. В історії медицини відомий пацієнт H. M. Зазвичай, коли публікують медичні дані конкретної людини, її ім’я приховують. Але справжнє ім’я H. M. відоме — це Генрі Молісон, і він є найбільш
дослідженим пацієнтом за всю історію.

Дитиною Генрі впав з велосипеда й отримав травму мозку. Унаслідок цього в нього розвинулися епілептичні
запам’ятав до операції. Проте
(див.
Самоконтроль

1. Відповідь на подразнення за участі нервової системи називають А таксисом В тропізмом Б рефлексом Г подразливістю
2. Прикладом безумовного рефлексу може бути А реакція людини на власне ім’я
Б пересування людини на ковзанах
В відсмикування руки від гострого предмета Г виділення слини при згадуванні смачної страви
3. Збереження та відтворення інформації
А увагою
Б емоцією
В пам’яттю
Г мисленням
4. Проаналізуйте наведену на рисунку ситуацію.
Який темперамент притаманний людині, у якої пошкодили капелюха?
А холеричний
Б сангвінічний
В флегматичний
Г меланхолічний

5. Як приклад інстинктивної поведінки можна навести А захист немовляти матір’ю від загроз
Б поворот голови в напрямку сильного звуку В відсмикування руки від гарячого предмета Г чхання при
6. Одним із гормонів, який бере участь у регулюванні стану сну, є А тироксин В мелатонін Б окситоцин Г соматотропін
8. Суб’єктивне
9. Допишіть правильно твердження: «Моторна пам’ять …. А триває кілька секунд або хвилин Б пов’язана із лімбічною системою мозку В обумовлює формування рухових навичок Г забезпечує можливість розповісти зміст статті
Тестові завдання з однією відповіддю (1,5 бала)
10. Проаналізуйте твердження стосовно пам’яті людини.
І. За осмисленого запам’ятовування інформація зберігається недовго.
ІІ. Для запобігання перевантаження мозку частина інформації не зберігається.
Чи є поміж них правильні? А правильне лише І В обидва правильні
Умовні рефлекси
1 притаманні всім особинам одного виду 2 є вродженими
Умовою формування є
1
передування
нейтрального
стимулу
безумовному
2
3 випадкове

деякі інші залози, уретру (іл. 217). Сім’яники, або яєчка
що продукують сперматозоїди після статевого дозрівання, а також утворюють статеві гормони, зокрема тестостерон. Сім’яники розвиваються в черевній порожнині, а невдовзі після народження опускаються до шкірно-м’язового мішечка мошонки. Сім’яники містять звивисті сім’яні канальці, які виходять із товщі яєчка й формують
Усі канальці впадають в
дить у сім’явиносну протоку. Біля
сім’яних
мошонку й статевий член. У ньому розрізняють корінь, тіло й головку. На верхівці головки розташований отвір уретри. Біля основи головки шкіра утворює складку
Іл. 217. Чоловіча статева

жінки відносять яєчники, матку та піхву (іл. 218). Яєчники невеликі парні органи округлої форми, що продукують яйцеклітини й утворюють жіночі статеві гормони. Яєчник складений з мозкової та кіркової речовини.
У кірковій речовині містяться невеликі за розміром пухирці фолікули. У них відбувається утворення яйцеклітин. У мозковій речовині прохо-
дять кровоносні судини та нерви. Яйцеклітини утворюються внаслідок поділу клітин, який починається ще до народження дівчинки. Завершення поділу відбувається
це м’язовий порожнистий орган. З одного боку вона сполучається з піхвою, з іншого формує маткові (фалопієві) труби.
черевну порожнину отвором.
у яєчнику, потрапляють до порожнини
клітор

за будовою чоловічі та
статеві клітини (гамети). Їхньою особливістю є половинний (гаплоїдний) набір хромосом, що міститься в ядрах. Невеликі рухливі чоловічі
У людини сперматозоїд складається з головки, основну частину внутрішнього вмісту якої займає ядро, шийки та хвоста.
є джгутик, що забезпечує переміщення
тозоїда є важлива мембранна
ферментами, потрібними для розчинення
тини (іл. 219, а). Жіночі статеві
нами та енергією


статевих клітин, яке називають заплідненням. У людини сперма-
допомогою джгутика хвоста сперматозоїди рухаються
жінки. За
труб. Якщо вони досягають яйцеклітини, то можуть запліднити її. Запліднення починається з акросомної реакції, коли сперматозоїд взаємодіє з прозорою зоною яйцеклітини. За допомогою вмісту
оболонки, і сперматозоїд уводить у неї своє ядро. Після цього в мембрані яйцеклітини відбуваються зміни, що внеможливлюють злиття з нею іншого сперматозоїда. Гаплоїдні ядра яйцеклітини та сперматозоїда зливаються. З цього моменту клітина називається зиготою (іл. 220). Вона просувається за допомогою війкових
починається ембріональний розвиток
до її порожнини (§ 55). У процесі запліднення відновлюється диплоїдний



історія». Дослідники й дослідниці в галузі біології сказали б, що мовиться про онтогенез. В онтогенезі (індивідуальному розвитку) людини виділяють два періоди ембріональний (ембріогенез) та постембріональний. Сукупність фізіологічних процесів, що супроводжують та забезпечують
ональний розвиток, називають вагітністю. Особливості ембріогенезу хордових тварин.
ділиться. Особливість

мезодерма (іл. 221). Наступний етап розвитку називають органогенезом: формуються органи та системи органів. Різні зародкові листки
дають початок різним частинам організму. З ектодерми розвиваються зовнішні покриви та нервова система, з ентодерми травний канал і дихальна система, а клітини мезодерми утворюють скелет, м’язи та частину внутрішніх органів.
Вагітність. Вагітність у людини триває близько 280 діб. У ній виокремлюють три послідовні
зародковий і плодовий.
Початковий період триває
тиждень ембріонального розвитку. Перший поділ зиготи закінчується приблизно через 30 годин після запліднення. Надалі відбувається
бластули та гаструли. Зародок досягає порожнини матки за 5–7
Далі він занурюється в епітелій матки (фаза імплантації). Частина клітин формує ембріобласт частину зародка, з якої буде розвиватися безпосередньо плід. Інші клітини формують трофобласт те, з чого розвиватимуться зародкові оболонки (іл. 222).
Зародковий
восьмого тижня вагітності. На початку другого тижня розпочинається гаструляція, на третьому розвиток хорди, нервової трубки, серця
Іл. 222. Початковий період ембріогенезу людини (електронна мікрофотографія чотирьох бластомерів)

плід
проникнення багатьох токсичних речовин і більшості хвороботворних мікроорганізмів. Однак через плаценту можуть проникати деякі віруси (наприклад ВІЛ), бактерії (збудники сифілісу тощо), одноклітинні (токсоплазма тощо) та багатоклітинні (різні види гельмінтів) паразитичні тварини. Отже, захист плода материнським організмом не є абсолютним.
Наприкінці другого місяця довжина плода зростає до 20–25 мм майже половина довжини тіла припадає на
формуються риси обличчя, повіки, ніс, губи, очні западини, кінцівки, розпрямляється спина. У цей час, якщо клітини ембріона містять Y-хромосому, розпочинається формування плода за чоловічим типом. Наприкінці третього місяця розвиваються пальці.

період). Другий
з періодом формування зачатків органів). В останні два місяці зростає ризик передчасних пологів (іл. 224).
Пологи. Після закінчення цього строку в крові починає
ватися концентрація гормону задньої частки
який стимулює скорочення гладеньких м’язів матки та
розтягання стінок піхви.
вання плоду
такий рух відбувається головою плода вперед.
Після повного виходу немовляти з материнського організму перерізають
організму новонародженого киснем і видалення вуглекислого газу. Концентрація останнього поступово підвищується і спричинює стимуляцію дихального центру, що рефлекторно викликає
вдих. Перше розширення тканини легень пов’язане з больовими відчуттями, тому після першого вдиху дитина починає кричати. Запуск власного
моментом, який визначає життєздатність
дитини матка починає скорочуватися
з ембріональними
є

§ 56. Постембріональний
Український
«Можна»
існувати, можна думать — можна повторять». Це філософська думка, яка торкається
Постембріональний період розвитку людини поділяється на декілька етапів (іл. 225), які характеризуються
організмі. Новонароджені. Новонароджена дитина лише частково пристосована до самостійного життя. У неї не повністю
сенсорні системи, вона здатна сприймати
ників звуки, запахи, дотики.
пересування. Виживання дитини
піклування (іл. 226). Новонароджені
із яким надходять необхідні речовини та
скелета на момент народження, здебільшого заміщується на кісткову (цей процес триває до пізнього підліткового віку). У черепі новонародженої дитини відсутні шви, а кістки з’єднані з допомогою тім’ячок сполучнотканинних проміжків між кістками. Це необхідно для полегшення проходження голови через пологові шляхи. Протягом грудного періоду
відбувається заростання тім’ячок. На момент народження дитина не здатна добре бачити, що зумовлено функціональною несформованістю мозкової частини зорової сенсорної системи. Поступово ця здатність покращується. Дитинство. У цей період відбувається подальший ріст і розвиток організму. Діти починають самостійно ходити, навчаються сприймати мову інших людей і говорити самостійно. У процесі накопичення досвіду ускладнюється їхня поведінка.
Підлітковий та юнацький вік. Із початком статевого дозрівання діти переходять у підлітковий вік. Статеве дозрівання дівчаток починається раніше, ніж хлопців (іл. 227). Його причиною є збільшення секреції гіпофізом гонадотропних гормонів, які стимулюють виділення статевими залозами статевих гормонів. Розрізняють первинні та вторинні статеві ознаки. Первинні


Послідовність процесів, пов’язаних зі статевим дозріванням у дівчаток, є такою: ріст молочних залоз; поява волосся на лобку; поява волосся в пахвовій ділянці; відбувається менархе. У хлопців послідовність подій є такою: збільшення в розмірі сім’яників; зволосіння лобка; збільшення в розмірі статевого члена; поява
структура шкіри, пружність кровоносних судин. Старечий вік. Старіння може супроводжуватися розвитком хвороб старечого віку. Збільшується ймовірність розвитку інфаркту, інсультів, атеросклерозу, гіпертонії, хвороби Паркінсона (розлад рухової діяльності) та Альцгеймера (розумова слабкість) тощо. Ступінь згасання функціонування організму людини похилого віку залежить від стану організму в дорослому віці, а також способу життя (іл. 228). Описані незворотні зміни в організмі так чи інакше призводять до смерті людини. Розрізняють клінічну й біологічну смерть. Клінічна смерть характеризується зникненням видимих проявів життя: зупинкою серцебиття, дихання, деяких безумовних рефлексів, втратою свідомості. Критичним моментом у поверненні з цього стану є запуск дихання й кровообігу, що досягається штучним диханням, масажем або штучною електричною стимуляцією серця. Якщо це вдалося зробити
4–6 хвилин, людина
в клітинах організму відбуваються





§ 57. Репродуктивне
вносить істотні корективи у
програми розмноження. Ви вже знайомі з багатьма їхніми аспектами: гаметогенез, функціонування статевих органів, запліднення, ембріональний розвиток і народження. Репродуктивну поведінку контролюють статеві гормони, які активують вроджену поведінку. Проте в
чому можуть бути найрізноманітніші причини. Існує багато

ж імунологічна несумісність, коли імунна система виробляє антитіла проти сперматозоїдів, унеможливлюючи їхнє функціонування. У чоловіків безпліддя може бути зумовлене порушеннями сперматогенезу, дефектами формування джгутика, через що сперматозоїди втрачають здатність рухатися, а також іншими розладами. Такі проблеми часто можна розв’язати за допомогою досягнень сучасної медицини.
Репродуктивне здоров’я. Здоров’я репродуктивної системи має важливе значення не лише для розмноження. Значну кількість фізіологічних процесів регулюють статеві гормони, а тому репродуктивне здоров’я є запорукою тривалого нормального функціонування організму загалом (іл. 230). Зовнішні статеві органи мають чутливі слизові оболонки, тому за їх гігієною необхідно ретельно слідкувати. Значну проблему становлять хвороби, які передаються під час статевого контакту, збудниками яких можуть
СНІДу, герпесвірус генітального
у випадку гонореї,
гриби (Candida albicans у випадку кандидозу) або найпростіші (трихомонади). Наслідками цих
сексуальної функції (імпотенція), безпліддя й системні захворювання, які
закінчитися смертю. Варто
томними, що

яких видимих
але ймовірність передавання збудника (зараження) є високою. Тому використання презерватива повинно бути обов’язковим елементом статевого життя. Репродуктивна медицина. Ця галузь медицини в останні роки здобула велику популярність, оскільки щораз більше пар не може самостійно зачати дитину та вдається до допомоги медиків. Репродуктивна медицина це комплекс медико-біологічних знань і досвіду, спрямований на розв’язання проблеми дітонародження та планування сім’ї. Наразі репродуктивна медицина зробила крок уперед, завдяки чому з’явилися новітні методики, спрямовані на реалізацію репродуктивної функції пар, які не можуть зачати
що
за допомогою спеціальної
терапії провокують вироблення яйцеклітин, які
запліднюють у сприятливих умовах за допомогою сперми її чоловіка

запліднення, решта проходять кріозамороження для можливого повторного ЕКЗ. Проте використання ембріонів, що залишаються після ЕКЗ, викликає етичні дискусії. Крім того, є ризики, пов’язані з успішністю імплантації після кріозамороження. Сурогатне материнство застосовують тоді, коли жінка не може виносити дитину. Зокрема, коли в жінки трапляються часті викидні. Сутність методу полягає в тому, що сурогатній матері вводять у порожнину матки ембріон, який вона виношує. Прийняття рішення про використання цього методу репродуктивної медицини вимагає
подружжя.
Донорство яйцеклітини необхідне в тих випадках, коли організм жінки з якоїсь причини не може продукувати власні яйцеклітини або
не дозрівають.
жінки-донора дає можливість жінці виносити й народити дитину (іл. 232). Банк донорської сперми існує практично в кожній клініці репродуктивної медицини. У ньому виникає необхідність, якщо чоловік абсолютно безплідний. Наразі тривають
соціальних аспектів, переважно так званого права
на життя. Це зумовлено тим, що багато сучасних технологій пов’язані з використанням
розвитку є методики, використовувані




завдання, сурогатні матері мають бути здоровими не лише фізично, а й психічно, крім того, у них
повинні бути свої
діти.
У світі існують різні підходи до законодавчого врегулювання
питання сурогатного материнства, які відображено на карті (див. рисунок).
Завдання
важливість

Учень стверджував, що альтруїстична форма передбачає
ду. Учениця зауважила, що вимогою
фізичне здоров’я
Самоконтроль
Тестові завдання
1. На рисунку зображено
А нейрон
Б остеоцит
В яйцеклітину
Г сперматозоїд
2. Одношаровий зародок із
під час ембріогенезу, називають
А зиготою
Б бластулою
В гаструлою
Г нейрулою
3. Як називають процес
А вагітність
Б імплантація
В запилення
Г запліднення


4. Вірусне захворювання, що передається статевим шляхом, — це
А сифіліс
Б гонорея
В хламідіоз
Г ВІЛ-інфекція
5. Як називають процес прикріплення зародка до слизової оболонки матки?
А пологи
В імплантація
Б запліднення Г трансплантація
6. Статеве дозрівання організму людини відбувається в період А 1–3 роки В 8–18 років Б 4–7 років Г 18–30 років
Тестові
7. Проаналізуйте твердження

8. З ектодерми розвивається
А нервова система
Б дихальна система
В травний канал Г скелет і м’язи
9. У репродуктивній медицині застосовують метод
А енцефалографії
Б мічених атомів В ЕКЗ
Г ПЛР
Тестові завдання з однією відповіддю (1,5 бала)
10. Проаналізуйте твердження щодо зображеного на рисунку органа. І. На рисунку зображено яєчник.
ІІ. Буквою Х позначено дозрілий сперматозоїд.
Чи є з-поміж них правильні?
А правильне лише І
Б правильне лише ІІ
В обидва правильні
Г немає правильних

11. Прочитайте речення: «Сім’яники — парні органи, що продукують (1),
а також утворюють статеві гормони, зокрема (2)». Правильні варіанти для заповнення пропусків, позначених цифрами 1–2, наведено в рядку
А 1 яйцеклітини, 2 тироксин
Б 1 сперматозоїди, 2 тестостерон
В 1 сперматозоїди, 2 мелатонін
Г 1 яйцеклітини, 2 окситоцин
Тестове завдання з однією відповіддю
стовпчику (3 бали) 12. Роздивіться рисунок, на якому зображено деякі етапи ембріогенезу. Укажіть правильні твердження.

§ 58. Людина — біосоціальна істота
Сучасне людство належить до
розумна (Homo sapiens), роду Людина, родини Гомініди, ряду Примати, класу Ссавці. До родини гомінідів також належать сучасні людиноподібні мавпи — орангутанги, горили, шимпанзе, а також деякі вимерлі форми людей. Процес еволюційного розвитку нашого виду називають антропогенезом. Характерні особливості людини. Які характеристики вважають
притаманними переважно людині? Учені виокремлють кілька таких
ознак, і розвиток деяких з них можна простежити шляхом аналізування викопних решток. Це прямоходіння, розвинений головний мозок, пристосована для виготовлення та використання знарядь праці кисть руки, щелепи з невеликими зубами й невиразними іклами, а також втрата густого волосяного покриву на більшій частині шкіри. Етапи виникнення людини.
відома велика кількість викопних знахідок давніх гомінідів. Були види, які з часом поступово перетворювалися на інші, деякі види могли давати початок різним лініям. Одна з них привела до появи сучасної людини, інші до сучасних людиноподібних мавп, багато видів із часом вимерли. Ми опишемо лише основні етапи антропогенезу, які сьогодні не викликають заперечень у більшої частини наукової спільноти. Виникнення родини гомінідів розпочалося 18–15 млн років тому з тварин, до яких належав проконсул (іл. 233). Це був примат, що мешкав
Іл. 233. Реконструкція тіла проконсула (а) та одного з перших людей сучасного типу (б)

будову тіла між мавпами
завдяки будові стоп і кистей рук значну частину часу проводили
Одна з гілок розвитку австралопітеків дала початок
є Людина рудольфійська (Кенія, 2,3–1,5 млн років тому). Визначним етапом антропогенезу
ного літопису Людина вміла (Африка, 2,3–1,5 млн років тому).




тому), який згодом поширився
теренах України. Раніше вважалося, що неандертальці були прямими предками сучасної людини, наразі цей погляд уважають хибним.
Вид Людина розумна виник унаслідок еволюції
людей Африки. Найдавніші кістяки людей із сучасною будовою датують 200 тис. років тому, їх було знайдено на території Ефіопії. Унаслідок
збільшення кількості й розселення популяцій люди почали мігрувати
з Африки й розселятися в Європі та Азії. Чинники антропогенезу. Еволюція людини відбувалася під дією
біологічних і соціальних чинників. До соціальних чинників антропогенезу відносять працю, суспільний спосіб життя, розвинену свідомість і мову. На пізніших етапах становлення людини їм належала
роль. Найважливіший чинник еволюції людини праця. Упродовж життя багатьох поколінь унаслідок природного добору зберігалися особини зі спадковими змінами, що сприяло прямоходінню. Прямоходіння спричинило вивільнення руки. Розвинена рука вможливила виготовлення людиною примітивних знарядь праці. Спільна трудова діяльність сприяла об’єднанню членів колективу, що потребувало спілкування за допомогою

Аналізуємо інформацію, робимо висновки
Ознайомтеся з інформацією та виконайте завдання.
Нобелівська премія та антропогенез
Людство завжди цікавилося своїм походженням. Чим ми, Homo sapiens, відрізняємося від інших споріднених
видів? Багато інформації щодо цих
питань надавали нам класичні дослідження кісток і місць стоянок давніх
людей. Проте шведський науковець Сванте Паабо значно вдосконалив методи занурення в минуле нашого родоводу. За дослідження еволюції
людини вчений здобув

2022 року в галузі фізіології або медицини.
Спочатку з невеликого шматка кістки неандертальця (вимерлого виду) ученому вдалося вилучити
лася близько 75 тис. років тому. Людина розумна досягла Південної Азії (50 тис. років тому), Австралії (46 тис. років тому), Європи (43 тис. років тому), Східної Азії (30 тис. років тому). Дата початку заселення Америки є спірною, її відносять до діапазону 30–14 тис. років тому. Конкуренція з неандертальцями на територіях спільного проживання призвела до вимирання останніх.
Карта міграції виду Людина розумна (числа позначають час відповідних
генетики й молекулярної біології. Учениця зауважила, що досліджували молекули
А лише учень Б лише учениця
В обоє
Чи досягнуто результатів
Тема 1–4
Досліджую природу
1. Під час проведення дослідження
було виявлено зайву
Який метод було застосовано?
А мікробіологічний
Б цитологічний
В гістологічний
Г біохімічний
2. Ознайомтеся з переліком
1 — планування дослідження
2 — формулювання гіпотези дослідження
3 — аналізування результатів
4 — проведення експерименту
Правильна послідовність
А 2 – 1 – 4 – 3
Б 3 – 4 – 2 – 1
В 1 – 2 – 3 – 4
Г 1 – 3 – 4 – 2 3. На уроці учень досліджував
в рядку


моделі й визначив назви його відділів. Проаналізуйте відповіді учня (І, ІІ).
І. Позначений цифрою
стовбуром мозку. ІІ. Відділ, позначений цифрою 2, учень назвав довгастим мозком.



сунку. Добавили розчин слини Слина + крохмаль Крохмаль
Дайте відповіді на питання.
Про розщеплення якої сполуки свідчить
зникнення синього кольору розчину?
1 крохмалю
2 білків
3 жирів
У яку частину травної системи
відкриваються
протоки залоз, що виробляють слину?
1 ротову порожнину
2 тонку кишку
3 шлунок


Який фермент працює в слині?

Г обидва помиляються
8. Ознайомтеся із зображенням відділу опорно-рухової системи
людини, на якому зрослі кістки позначено цифрами (1–3). Використавши інтернет-джерела, укажіть правильні назви цих кісток.
А 1 сіднична, 2 клубова, 3 лобкова
Б 1 клубова, 2 сіднична, 3 лобкова
В 1 сіднична, 2 лобкова, 3
клубова
Г 1 клубова, 2 лобкова, 3 сіднична
9. Розпізнайте представників різних
А – В. Виберіть правильні






10.




12.





Наука, предметом
вивчення якої є процеси життєдіяльності організмів, — це
1 анатомія
2 фізіологія
3 цитологія
людини. Оцінювання роботи
Будову, життєдіяльність та різноманітність клітин вивчає Розвиток еволюційної біології
вможливив пояснення
1 біохімія
2 генетика
3 цитологія
1 причин інфекційних хвороб
2 впливу тютюнопаління на організм
3 закономірностей історичного розвитку органічного світу
Чи досягнуто результатів навчання?
Тема 5–10
Досліджую природу


1. Унаслідок проведених досліджень у крові людини було виявлено підвищений рівень глюкози порівняно з нормою. Метод, який було застосовано, — А мікробіологічний Б цитологічний В гістологічний Г біохімічний
2. Прочитайте речення: «Низка методів скерована на вивчення функціонування внутрішніх органів: (1) реєструє електричну активність серця, а (2) — головного мозку». Правильний варіант для заповнення
пропусків, які позначено цифрами (1, 2), наведено в рядку
А 1 електрокардіографія, 2 спірометрія
Б 1 спірометрія, 2 електроенцефалографія
В 1 електрокардіографія, 2 електроенцефалографія
Г 1 електроенцефалографія, 2 електрокардіографія 3.

відповідним
Номери сполук, що є спільними для рідин (у нормі), уписано у фігури на перетині кіл, а сполук, що притаманні лише одній рідині (у нормі), — у відповідному колі поза перетинами.

Г волосяна сумка








12. Згадайте будову та функціонування легеневих
нефрона.
Проаналізуйте наведені твердження.
І. Обидві структури контактують із стінкою
ІІ. Ефективність роботи обумовлена
одношаровим епітелієм.
Чи є поміж них правильні?
А правильне лише І
Б правильне лише ІІ
В обидва правильні
Г немає правильних
13. Одним із заходів попередження серцево-судинних хвороб є
А уникнення перевтоми й стресових ситуацій Б контролювання кількості
дотримання правил
14. Ознайомтеся з переліком
1 — бронхи,
2 — носова порожнина,
3 — трахея,
4 — гортань,
5 — легені.
Правильна
1
15.


Представників видів, які є
гомойотермними, позначено
1 лише буквою В
2 лише буквами Б та В
3 буквами А, Б та В

Загальною ознакою
для представників
видів, які позначено
буквам Б та В, є
1 здатність до прямоходіння
2 розвинена свідомість і мова
3 вигодовування
ня власного організму.
Оцінювання роботи Група результатів № завдання
природу 1, 2, 3, 4 5 6
13,14 15 16

Позначені буквою В представники виду, на відміну від інших
зображених видів,
2 дихають за допомогою легень
3 мають другу сигнальну систему
Кількість балів
Предметний
Анаболізм 74
Вітаміни 86
Внутрішнє дихання 134
Внутрішнє середовище організму 22
Втома 66
Гіподинамія 67
Гіпоталамо-гіпофізарна система 47
Гомеостаз 23
Гормони 40
Гуморальна регуляція 40
Динамічна робота м’язів 66
Енергетичний баланс харчового
раціону 91
Еритроцити 102
Здоров’я 7
Зовнішнє дихання 134
Імунітет 122
Імунотерапія 128
Катаболізм 74
Клітина 14
Кров’яний тиск 116
Лейкоцити 106
Лімфа 120
Лінійна швидкість руху крові 117
Медіатори 25
Метаболізм (обмін речовин) 74
Міофібрили 61
Нейрогуморальна регуляція 17
Нейрони 24
Неспецифічний гуморальний
імунітет 122
Неспецифічний клітинний
імунітет 123
Орган 15
Орган 15
Проміжні (інтернейрони) 27
Пульс 116
Раціональне харчування 90
Рефлекс 26
Рефлекторна дуга 27
Рухові (моторні) нейрони 26
Серце 111
Синапси 24
Специфічний гуморальний
імунітет 123
Специфічний клітинний імунітет 124
Статична робота м’язів 66
Травлення 78
Тромбоцити 108
Фізіологічна система органів 15
Функціональна система органів 16
Хвороба 7
Чутливі (сенсорні) нейрони 26
Перелік
використаних
1. Чернінський А. О. Біологія людини. Олімпіадний мінімум. Х. : Вид.група «Основа», 2013 303 c. ISBN 978-617001744-4
2. Ґанонґ Вільям Ф. Фізіологія людини: Підручник / Переклад з англ. Наук. ред. перекладу М. Гжегоцький, В. Шевчук, О. Заячківська. Львів : БаК, 2002. 784 с. ISBN 966-706538-3.
3. Загальна цитологія та гістологія. Частина І: Загальна цитологія: Навчальний посібник.– К.: Видавничо-поліграфічний центр «Київський університет», 2006. – 275 с.
4. The Human Nervous System Edited by: Jürgen K. Mai and George Paxinos / Third Edition, Academic Press 2012, 1415 p.
5. C. Barbaranelli et al. A questionnaire for measuring the Big Five in late childhood / Personality and Individual Differences 34 (2003) 645–664
6. Gosling, S. D., Rentfrow, P. J., Swann, W. B., Jr. (2003). AVery Brief Measure of the Big Five PersonalityDomains. Journal of Research in Personality, 37,504-528.
doi:10.1016/S0092-6566(03)00046-1
7. Klimanska, M., & Haletska, I. (2019). UKRAINAIN ADAPTATION OF THE SHORT FIVE FACTOR PERSONALITY QUESTIONNAIRE TIPI (TIPI-UKR). PSYCHOLOGICAL JOURNAL, 5(9), 57–76. https://doi.org/10.31108/1.2019.5.9.4
26.
§
§ 45.
§ 47.
§ 48.
§ 49. Фізіологічні
§ 50. Свідомість
§ 51.
§ 52. Біологічні основи індивідуальності
Аналізуємо інформацію, робимо
Самоконтроль рівня навчальних
ТЕМА 10. Репродукція та індивідуальний розвиток
людини
§ 53. Репродуктивна система
§ 54. Статеві клітини.
§ 55. Онтогенез. Ембріональний період
§ 56. Постембріональний
§ 57. Репродуктивне
Підручник відповідає Державним санітарним нормам і правилам «Гігієнічні вимоги до друкованої
Підготовка оригінал-макета Олена Корбуш Редактор, коректор Андрій Панченков Художники Олексій Глазунов, Сергій Бебс Художниця обкладинки Ірина Шпак Створення та підготовка е-додатка Марія Корбуш, Олександр Корбуш
Формат 70х100/16. Обл.-видавн. 16.76. Гарнітура Шкільна. Підписано до друку ??.??.2025. Умов. друк. арк. 20.8. Друк офсет. Тираж ????? пр. Зам. № ________.
Виготовлено згідно зі СОУ 18.1-02477019-07:2015 (Зі змінами)
Учбово-видавничий центр «Школяр» 02094, Київ, вул.Сергієнка, 18 Свідоцтво ДК № 7925 від 04.09.2023 р. Тел.: 066-061-01-76, 063- 280-78-83, 067-209-60-88 www. shkolyar.com.ua E-mail: shkolyar_info@ukr.net


